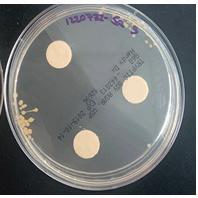
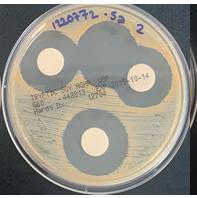
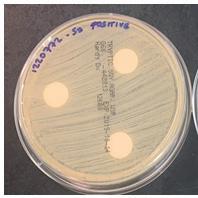

ENDODONTICS
INDEX US : Shop.BrasselerUSA.com or 800.841.4522 | Canada : Shop.Brasseler.ca or 800.363.3838 1 EndoRing® is a registered trademark of Jordco, Inc. Access & Initial Preparation Endo Solutions Pulp Vitality Spray 2 True™ Dental Dam 2 EndoSequence® Flowable Dam Material 3 enLite™ Curing Light 3 Access Instruments 4 Gates Glidden 6 Peeso Reamers 6 Muellers 6 Nerve Broaches 6 ESX® Modern Access Kit 7 BioRaCe™ Access Kit 7 EndoSequence® Access Kit 7 Hand Files KontrolFlex™ 8 RazorFlex™ 9 EndoSequence® 10 NiTi File Systems EndoSequence® CM 12 EndoSequence® Scout Files 14 EndoSequence® VT Scout 16 ESR™ CM 18 ESR™ 20 XP-3D™ 22 EndoSequence® 24 ESX® 26 ScoutRaCe™ 28 BioRaCe™ 29 BT RaCe™ 30 RaCe™ 31 RazorFlex™ 32 EndoSequence® Apical Verifiers 33 Irrigation & Lubricant Triton® All-in-One Irrigation Solution 34 Endo Solutions 36 Endo Solutions Irrigation Syringes 36 Endo Solutions Irrigation Needles 36 Endo Solutions Caddy 37 EndoSequence® Lubricant 37 EndoSequence® Canal Clean™ 37 Obturation Materials EndoSequence® BC Sealer™ 40 EndoSequence® BC Points™ & Pellets™ 42 Obturation Materials EndoSequence® Gutta Percha & Paper Points 43 Activ GP™ Sealer & Points 44 Standard & Accessory Gutta Percha 45 Finger Spreaders & Finger Pluggers 45 Paste Fillers 45 EndoSequence® BC Temp™ 46 Root Repair Material EndoSequence® BC RRM™ 48 Base/Liner & Core Build-Up Material EndoSequence® BC Liner™ 50 EndoSequence® CBM+™ 52 Post Systems EndoSequence® Post System 53 DentFlex™ Post System 55 Vlock™ & Vario™ Titanium Post Systems 55 Power Systems EndoSync™ Plus 56 EndoSync™ A.I. 57 EndoSequence® 2 58 EndoDrive Plus™ 58 EndoPro 270™ 59 Ultrasonics Forza™ V3 60 Ultrasonic Tips 61 Hand Instruments Hand Instruments 65 Surgical Hand Instruments Endo Black™ Premium Instruments 70 Procedure Systems XP-3D™ Kits 76 ESR™ CM Kits 77 EndoSequence® Blend Kits 78 EndoSequence® Kits 79 ESX® Kits 81 BioRaCe™ Kits 83 Ultrasonic Tip Kit 84 Post Kit 84 Organizational Systems Aluminum Bur Blocks 85 Endo Solutions Caddy 86 EndoRing® II 86 EndoSwipe™ 87
Endo Solutions Pulp Vitality Spray

• A quick and effective way to check cold sensitivity
• Significantly colder than ethyl chloride or ice
• For accuracy, use with micro applicators or cotton pellets
• Directional nozzle for easy placement on micro applicator or cotton pellet
Order No.
5026551U0
True™ Dental Dam


∙ Easily punched, stretched, and placed, supporting effective and efficient isolation set-up procedures
∙ Smoothly glides through contacts and tucks into the sulcus, allowing for true placement confidence
∙ Exceptionally durable and tear resistant, delivering the seal and tissue protection you expect and help to reduce contamination to create a clean, clear operative field
∙ Available in blue (latex) and purple (latex-free) to provide better color contrast with dentition
Medium Gauge
Heavy Gauge
ACCESS & INITIAL PREPARATION 2
Color ID Size (in.) Material Type Qty/Pk Thickness (mm) Order No. Blue 5x5 Latex 52 0.23 838252-B Blue 6x6 Latex 36 0.23 838236-B Purple 5x5 Latex-Free 50 0.22 838200-B Purple 6x6 Latex-Free 50 0.22 838201-B
Color ID Size (in.) Material Type Qty/Pk Thickness (mm) Order No. Blue 5x5 Latex 52 0.28 838253-B Blue 6x6 Latex 36 0.28 838237-B Purple 5x5 Latex-Free 50 0.25 838202-B Purple 6x6 Latex-Free 50 0.25 838203-B
EndoSequence® Flowable Dam Material
This light-cure heatless liquid dam and block-out resin can be applied to gingiva or tooth surfaces before root canal therapy, bleaching, sandblasting, or other procedures requiring intraoral protection. EndoSequence Flowable Dam Material is provided in pre-loaded syringes and is dispensed using minimum waste precision applicator tips. Upon completion of the procedure the flexible blue-colored material can quickly and easily be removed with a hand instrument.
• Flowable yet stackable consistency
• Fast light-cure and stays cool to the touch
• Flexible and tear resistant
• Stays put while still being easy to remove
enLite™ Curing Light

• 360° Swivel Light Guide
• 420~490 nm Wavelength
• Digital Display
• Lightweight, Cordless
• Powerful, Rechargeable Lithium-Ion B
• Digital Display
• 3 Curing Modes
• 1,600 mW/cm Light Intensity
EndoSequence® Flowable Dam Material: Flowable Dam Syringes (3ml ea.)

Safety Data Sheet (SDS)
5028289U0
enLite™ LED Curing Light Complete Set:
1 enLite
1 Charging Base
1 AC Adapter
1 Light Guide
1 Anti-Glare Sleeve
1 Anti-Glare Cone
Order No. 5027697U0
ACCESS & INITIAL PREPARATION US : Shop.BrasselerUSA.com or 800.841.4522 | Canada : Shop.Brasseler.ca or 800.363.3838 3
•
Access Instruments







ACCESS & INITIAL PREPARATION 4 801 Head Size (1/10 mm) 012 014 016 018 023 029 Cutting Length (mm) - - - - -Friction Grip DuraCut™ (DC) 801DC 801DC - 801DC 801DCSuper-Coarse - - 5801 5801 5801 5801 835 Head Size (1/10 mm) 010 012 Cutting Length (mm) 4.0 4.0 Friction Grip Super-Coarse 5835 5835 15802 Head Size (1/10 mm) 012 014 016 018 Cutting Length (mm) 10.0 10.0 10.0 10.0 Friction Grip DuraCut™ (DC) 15802DC 15802DC - 15802DC Super-Coarse 15802 - 15802 15802 856 Head Size (1/10 mm) 014 016 018 021 025 Cutting Length (mm) 8.0 8.0 8.0 8.0 8.0 Friction Grip DuraCut™ (DC) 856DC 856DC 856DC -Super-Coarse 5856 5856 5856 5856 5856 857 Head Size (1/10 mm) 014 Cutting Length (mm) 10.0 Friction Grip Medium 857 851 Head Size (1/10 mm) 012 016 Cutting Length (mm) 8.0 8.0 Friction Grip Medium 851 851 805 Head Size (1/10 mm) 016 Cutting Length (mm)Friction Grip Super-Coarse 5805
Diamonds (5/Pack) FRICTION GRIP 31 - FG 1.60 mm 19 mm 1.60 mm 36 - FG/Surg 25 mm RIGHT ANGLE LATCH 2.35 mm 21 - RA 22 mm DIAMOND GRIT SIZES DuraCut™ (DC) 151 micron Super-Coarse = 150 micron Medium = 100 micron 2.35 mm 24 - RA/Surg 26 mm
Access Instruments
Carbides (5/Pack)















ACCESS & INITIAL PREPARATION : Shop.BrasselerUSA.com or 800.841.4522 | Canada : Shop.Brasseler.ca or 800.363.3838 5 H1S Us No. 2S 4S 6S 8S Head Size (1/10 mm) 010 014 018 023 Cutting Length (mm) - - -Friction Grip 31 - FG (19 mm) FG FG FG FG 36 - FG/Surg (25 mm) FG SURG FG SURG FG SURG FG SURG Right-Angle Latch 21 - RA (22 mm) RA RA RA RA 24 - RA/Surg (26 mm) RA 24 RA 24 RA 24 RA 24 H17 Us No. 1930 1931 1932 Head Size (1/10 mm) 009 010 012 Cutting Length (mm) 2.2 2.6 3.0 Friction Grip 31 - FG (19 mm) FG FG FG H34 Us No. -Head Size (1/10 mm) 010 012 Cutting Length (mm) 2.0 2.0 Friction Grip 31 - FG (19 mm) FG FG H31B Us No. 1957 1958 Head Size (1/10 mm) 010 012 Cutting Length (mm) 4.2 4.2 Friction Grip 31 - FG (19 mm) FG FG H269GK Us No. -Head Size (1/10 mm) 012 016 Cutting Length (mm) 9.0 9.0 Friction Grip 31 - FG (19 mm) FG FG Us No. 557MX 330MX 245MX 1557MX Head Size (1/10 mm) 4.2 1.6 2.8 4.2 Cutting Length (mm) 010 008 008 010 Friction Grip 31 - FG (19 mm) FG FG FG FG Us No. 557SC 330SC 331SC 245SC 1557SC 1558SC Head Size (1/10 mm) 3.7 2.0 1.9 2.7 3.9 4.0 Cutting Length (mm) 010 008 010 008 010 012 Friction Grip 31 - FG (19 mm) FG FG FG FG FG FG 36 - FG/Surg (25 mm) - - - - - FG 36
Compare to Endo-Z™ Endo-Z™ is a trademark of Dentsply International.
Gates Glidden

Color Coded (5/Pack)
With Rings (6/Pack)
Short - Color Coded (5/Pack)
Short - With Rings (6/Pack)

Peeso Reamers
Color Coded (5/Pack)
With Rings (6/Pack)
Muellers
Color Coded (5/Pack)
Nerve Broaches

Color Coded (12/Pack)

ACCESS & INITIAL PREPARATION 6
Tip ID Tip Size 15 mm White 050 018227U0 Yellow 070 018229U0 Red 090 018231U0 Blue 110 018233U0 Green 130 018235U0 Black 150 018237U0 Assortment 050-150 5013655U0 Tip ID Tip Size 15 mm 1 Ring 050 5006747U0 2 Rings 070 5006748U0 3 Rings 090 5006749U0 4 Rings 110 5006750U0 5 Rings 130 5006751U0 6 Rings 150 5006752U0 Assortment 050-150 5006753U0 Tip ID Tip Size 11 mm 1 Ring 050 5017689U0 2 Rings 070 5017690U0 3 Rings 090 5017691U0 4 Rings 110 5017692U0 5 Rings 130 5017693U0 6 Rings 150 5017694U0 Assortment 050-150 5017695U0 Tip ID Tip Size 16 mm 1 Ring 070 5006754U0 2 Rings 090 5006755U0 3 Rings 110 5006756U0 4 Rings 130 5006757U0 5 Rings 150 5006758U0 6 Rings 170Assortment 070-170 5006760U0 Tip ID Tip Size 11 mm XXXF 025 5014466U0 XXF 030 5014467U0 XF 035 5014468U0 F 040 5014469U0 M 050 5014470U0 C 060 5014471U0 Tip ID Tip Size 11 mm White 050 018226U0 Yellow 070 018228U0 Red 090 018230U0 Blue 110 018232U0 Assortment 050-110 018359U0 Tip ID Tip Size 16 mm Yellow 090 011698U0 Red 110 011699U1 Tip ID Tip Size 14 mm White 090 5013522U0 Yellow 100 5013523U0 Red 120 5013524U0 Blue 140 5013525U0 Green 160 5013526U0 Black 180 5013527U0 Assortment 090-160 5013521U0
ESX® Modern Access Kit

BioRaCe™ Access Kit


EndoSequence® Access Kit

ACCESS & INITIAL PREPARATION US : Shop.BrasselerUSA.com or 800.841.4522 | Canada : Shop.Brasseler.ca or 800.363.3838 7
K0218 US No. - - - 4 2 Figure No. 6850 6801 H34L H1 H1 Head Size (1/10 mm) 023 016 012 014 010 Cutting Length (mm) 10.0 1.6 3.5 1.4 1.0 Shank Type FG FG FG FG SURG RA SURG Quantity 1 1 1 1 1 Order No. 5020020U0 Order No. 5024555U0 K0284 US No. 1558SC 1557SC – – – 4 Figure No. H031RS H031RS 5909 6801DC 6856DC H1 Head Size (1/10 mm) 012 010 040 014 014 014 Cutting Length (mm) 4.0 3.9 1.0 – 8.0 RA SURG RA SURG Shank Type FG FG FG FG FG 1 Quantity 1 1 1 1 1 K000032 US No. 2 4 701L - - - - - 2 4 Figure No. H1 H1 H33L H34L 6801 6379 6850 5850 H1 H1 Head Size (1/10 mm) 010 014 012 012 016 023 023 018 010 014 Cutting Length (mm) 1.0 1.4 6.0 3.5 1.6 4.2 10.0 10.0 1.0 1.4 Shank Type FG FG FG FG FG FG FG FG RA SURG RA SURG Quantity 1 1 1 1 1 1 1 1 1 1 Order No. 5008861U0
KontrolFlex™
• Calibrated with stops for length measurement
• Manufactured of high quality stainless steel
• Optimal combination of strength and flexibility
Standard K-Files (6/Pack)
• Only K-Files available in 19 mm length Compare







Stiff K-Files (6/Pack)
5019068U0 5011701U0
Hedstrom Files (6/Pack)
K-Reamers (6/Pack)
Yellow
- 5011806U0 5011819U0
Red 25 - 5011807U0 5011820U0
Blue 30 - 5011808U0 -
Green 35 - 5011809U0 -
Black 40 - 5011810U0 -
HAND FILES 8
19 mm 25 mm 21 mm 31 mm
to
is a trademark of Dentsply International. File/Tip ID Tip Size 21 mm 25 mm 31 mm White 15 5011757U0 5011768U0Yellow 20 5011758U0 5011769U0 5011780U0 Red 25 5011759U0 5011770U0 5011781U0 Blue 30 5011760U0 5011771U0 5011782U0 Green 35 5011761U0 5011772U0 5011783U0 Black 40 5011762U0 5011773U0 5011784U0 Assortment 15-40 5011767U0 5011778U0 5011789U0 White 45 5011763U0 5011774U0 5011785U0 Yellow 50 5011764U0 5011775U0 5011786U0 Red 55 - 5011776U0 5011787U0 Blue 60 5011766U0 5011777U0 5011788U0 File/Tip ID Tip Size 21 mm 25 mm 31 mm Gray 08 5011790U0
5011816U0 Purple 10
15
C-File™ C-File™
5011803U0
5011791U0 5011804U0 5011817U0 White
5011792U0 5011805U0 5011818U0
20
File/Tip ID Tip Size 19 mm 21 mm 25 mm 31 mm
06
5011721U0Gray 08 5019069U0 5011702U0 5011722U0 5011741U0 Purple 10 5019070U0 5011703U0 5011723U0 5011742U0 White 15 5019071U0 5011704U0 5011724U0 5011743U0 Yellow 20 - 5011705U0 5011725U0 5011744U0 Red 25 - 5011706U0 5011726U0 5011745U0 Blue 30 - 5011707U0 5011727U0 5011746U0 Green 35 - 5011708U0 5011728U0 5011747U0 Black 40 - 5011709U0 5011729U0 5011748U0 Assortment 15-40 - 5015517U0 5015518U0 5015519U0 White 45 - 5011710U0 5011730U0 5011749U0 Yellow 50 - 5011711U0 5011731U0 5011750U0 Red 55 - 5011712U0 5011732U0 5011751U0 Blue 60 - 5011713U0 5011733U0 5011752U0 Green 70 - 5011714U0 5011734U0 5011753U0 Black 80 - 5011715U0 5011735U0 5011754U0 Assortment 45-80 - 5017696U0 5017697U0 5015520U0 File/Tip ID Tip Size 21 mm 25 mm Pink 06 5012644U0 5012645U0 Gray 08 5011716U0 5011736U0 Purple 10 5011717U0 5011737U0 White 15 5011718U0 5011738U0
Pink
• Slightly more flexible than KontrolFlex
RazorFlex™ Standard K-Files (6/Pack)
File/Tip ID Tip Size 21 mm 25 mm
Gray 08 5007557U0 5007585U0
Purple 10 5007558U0 5007586U0
White 15 5007559U0 5007587U0
Assortment 08-15 5024054U0* 5024055U0*
Yellow 20 5007560U0 5007588U0
Red 25 5007561U0 5007589U0
Blue 30 5007562U0 5007590U0
Green 35 5007563U0 5007591U0
Black 40 5007564U0 5007592U0
Assortment 15-40 5018035U0 5018036U0
White 45 5007565U0 5007593U0
Assortment 20-45 - 5024056U0*
Yellow 50 5007566U0 5007594U0
Red 55 5007567U0 5007595U0
Blue 60 5007568U0 -

Green 70 5007569U0 5007597U0
Black 80 5007570U0 -

Assortment 45-80 5015648U0 5015649U0
White 90 - 5007599U0
Yellow 100 - 5007600U0
Red 110 - 5007601U0
Blue 120 - 5007602U0
Green 130 - 5007603U0
Black 140 - 5007604U0
Stiff K-Files (6/Pack)
File/Tip ID Tip Size 21 mm 25 mm
Gray 08 5007621U0 5007624U0
Purple 10 5007622U0 5007625U0
White 15 5007623U0 5007626U0
Assortment 08-15 5024016U0* 5024053U0*
Hedstrom Files (6/Pack)

File/Tip ID Tip Size 21 mm 25 mm
White 15 5007574U0 5007607U0
Yellow 20 5007575U0 5007608U0
Red 25 5007576U0 5007609U0
Blue 30 5007577U0 5007610U0
Green 35 - 5007611U0
Black 40 5007579U0 5007612U0
White 45 - 5007613U0
Yellow 50 - 5007614U0
Blue 60 - 5007616U0
Green 70 - 5007617U0
Black 80 - 5007618U0
• Available in larger sizes (up to 140) *Sterile
HAND FILES US : Shop.BrasselerUSA.com or 800.841.4522 | Canada : Shop.Brasseler.ca or 800.363.3838 9
EndoSequence®
• Available in non-ISO sizes (012 & 017)

K-Files (6/Pack)
HAND FILES 10
File/Tip ID Tip Size 21 mm 25 mm Gray 08 5010770U0 5009085U0 Purple 10 5010771U0 5009024U0 Periwinkle 12 5010772U0 5009086U0 White 15 5010773U0 5009025U0 Beige 17 5010774U0 5009087U0 Yellow 20 5010775U0 5009026U0 Assortment 08-20 5010776U0 5009028U0
Reference Guides
NiTi File Systems Cross Reference
Fire™
CM Endo-Eze™ Genius® Ultradent® ESR™ CM
Vortex® Dentsply® EndoSequence®
ProTaper® Dentsply® EndoSequence® CM Taper
ProFile® Dentsply® EndoSequence® Scout Files
ProFile GT® Dentsply® EndoSequence® Scout Files
Non-Heat Treated Rotary
ProTaper Next® Dentsply® ESX® & EndoSequence® CM
K3™ Kerr™/SybronEndo® EndoSequence® & EndoSequence® Scout Files
K3™ XF Kerr™/SybronEndo® EndoSequence® CM
TF™ Twisted Files Kerr™/SybronEndo® EndoSequence® CM
Vortex Blue® Dentsply® EndoSequence® CM
ProTaper Gold® Dentsply® EndoSequence® CM Taper
ProTaper Ultimate™ Dentsply® EndoSequence® CM Taper
TruShape® Dentsply® XP-3D®
HyFlex® CM Coltene® EndoSequence® CM
Heat Treated Rotary
V-Taper™ 2 SS White® EndoSequence® VT Scout Files
DC Taper™ SS White® EndoSequence® VT Scout Files
EdgeFile® X7 EdgeEndo® EndoSequence® Scout
EdgeTaper Platinum™ EdgeEndo® EndoSequence® CM Taper
EdgeSequal™ Sapphire EdgeEndo® EndoSequence® CM
EdgeTaper Encore™ EdgeEndo® EndoSequence® CM
NiTi FILE SYSTEMS US : Shop.BrasselerUSA.com or 800.841.4522 | Canada : Shop.Brasseler.ca or 800.363.3838 11
File Type Brand Company Comparable Brasseler System Reciprocating WaveOne®
Dentsply® ESR™ CM EdgeOne
EdgeEndo® ESR™ CM EdgeOne
EdgeEndo® ESR™
SafeSiders® EDS® ESR™ CM Tango-Endo™ EDS® ESR™
Gold
Platinum™
CM
ProFile®, ProFile GT®, ProTaper®, ProTaper Gold®, ProTaper Next®, ProTaper Ultimate™, TruShape®, Vortex®, Vortex Blue®, and WaveOne® Gold are registered trademarks of Dentsply Sirona, Inc. HyFlex® is a registered trademark of Coltene Holding AG. EdgeFile® X7, EdgeOne Fire™, EdgeOne Platinum™, EdgeSequal™ Sapphire, EdgeTaper Encore™, EdgeTaper Platinum™, and V-Taper™ are registered trademarks of Edge Endo, LLC. SafeSiders®, Tango-Endo™, and EDS® are registered trademarks of Essential Dental Systems, Inc. K3™ and SybronEndo® are registered trademarks of Kerr Corporation. DC Taper™ is a registered trademark of SS White Burs, Inc. Endo-Eze™ Genius® is a registered trademark of Ultradent Products, Inc. Speed & Torque File System Speed Torque Reciprocation Motion EndoSequence® 500-600 RPM 1.8-2.3 NcmEndoSequence® CM 300-500 RPM 1.5-2.3 NcmEndoSequence® CM Taper 300-500 RPM 1.5-2.3 NcmEndoSequence® Scout File 300-500 RPM 0.6-2.0 NcmEndoSequence® VT Scout 300-400 RPM 4.0-5.2 NcmESX® 500-600 RPM 1.5 NcmESR™ 300-350 RPM - 150CCW-30CW to 170CCW-50CW ESR™ CM 300-350 RPM - 150CCW-30CW to 170CCW-50CW XP-3D™ 700-1000 RPM 1NcmBioRace™ 500-600 RPM 1.8-2.3 NcmScoutRace™ 600 RPM (curved); 900 RPM (calcified) -BT Race™ 600-800 RPM 1.5 NcmRaCe™ 500-600 RPM 1.8-2.3 NcmRazorflex™ 500-600 RPM 1.8-2.3 NcmEndoSequence® Apical Verifiers 500-600 RPM .5 Ncm -
EndoSequence® CM

THE PATENTED ENDOSEQUENCE ® DESIGN
The original EndoSequence file was introduced over 15 years ago, and despite the introduction of countless competitive files, EndoSequence remains one of the most popular files available today. The patented design and quality manufacturing set the EndoSequence file apart and make it one of the most efficient cutting files on the market.
WHAT YOU LOVE ABOUT ENDOSEQUENCE ® , MADE BETTER
EndoSequence CM Files are manufactured with an enhanced nitinol metallurgy and heat treatment process that allows for cutting edge fidelity and superior resistance to cyclic fatigue. EndoSequence CM provides clinicians with a more flexible option and an instrument that is significantly more resistant to separation.


ENDOSEQUENCE® CM PRODUCT OFFERING
Individual Packs (4/Pack)

NiTi FILE SYSTEMS 12
Calibration Markings Taper ID STERILE R File/ Tip ID Tip Size .04 Taper .06 Taper 21 mm 25 mm 31 mm 21 mm 25 mm White 15 5026609U0 5026617U0 5026625U0 5026633U0 5026639U0 Yellow 20 5026610U0 5026618U0 5026626U0 5026634U0 5026640U0 Red 25 5026611U0 5026619U0 5026627U0 5026635U0 5026641U0 Blue 30 5026612U0 5026620U0 5026628U0 5026636U0 5026642U0 Green 35 5026613U0 5026621U0 5026629U0 5026637U0 5026643U0 Black 40 5026614U0 5026622U0 5026630U0 5026638U0 5026644U0 White 45 5026615U0 5026623U0 5026631U0 -Yellow 50 5026616U0 5026624U0 5026632U0 -File/ Tip ID Tip Size Variable Taper 16 mm 21 mm 25 mm N/A SX/19 5027891U0 -Purple S1/18 - 5027892U0 5027899U0 White S2/20 - 5027893U0 5027900U0 Yellow F1/20 - 5027894U0 5027901U0 Red F2/25 - 5027895U0 5027902U0 Blue F3/30 - 5027896U0 5027903U0 Assortment SX-F3 - 5027898U0 5027905U0 Black F4/40 - 5027897U0 5027904U0
Triangular Cross Section Precision Safety Tip
PREMIUM BRASSELER QUALITY
EndoSequence CM files are ultra-premium NiTi files that adhere to extremely tight quality control specifications. Each step of the manufacturing process is meticulously controlled including our exclusive electopolishing process which provides the cleanest and sharpest cutting edge available on the market. EndoSequence CM files are provided in sterile blister packs to ensure that you are using the cleanest and most efficient cutting file for every procedure.
ELECTROPOLISHED SURFACE
• Eliminates surface imperfections that weaken other files
• Increases file sharpness
ENHANCED NITINOL METALLURGY
• Superior resistance to cyclic fatigue
• Allows for pre-bending for difficult access




• Deformation occurs prior to separation
• Cutting edge fidelity maximized at body temp

PRECISION TIP
Non-active at the tip, fully active precisely at 1mm
NO RADIAL LANDS
• Flexibility is maximized
• Torque is minimized
• Reduced cross section thickness
• Sharp cutting edge
PATENTED ACP (ALTERNATING CONTACT POINT™) DESIGN
• Non-landed, reduced-drag design
• Centers file within canal without radial lands
• Prevents self-threading “screw in” to canal
• Enhances debris removal
• Maximizes cutting efficiency
STERILE PACKAGING
• Eliminates cross-contamination
• Improves practice efficiency
NiTi FILE SYSTEMS US : Shop.BrasselerUSA.com or 800.841.4522 : Shop.Brasseler.ca or 800.363.3838 13
Vortex Blue® File
Vortex Blue® File
EndoSequence® CM File
2
EndoSequence® CM File
Vortex Blue® is a registered trademark of Dentsply Sirona, Inc. EndoSequence® CM 3 point engagement
point engagement 1 point engagement No engagement
EndoSequence® Scout Files
Working with multiple endodontists from different backgrounds, Brasseler has identified the most common limitations of files currently available on the market. Every feature of EndoSequence Scout Files has been designed to overcome these shortcomings.
Shortened cutting length (12mm) reduces maximum flute diameter and facilitates better scouting of the apical third

Exclusive NiTi allows for optimal pre-bending and flexibility
• Tighter flute structure and robust cross-section provides higher resistance to fatigue and deformation


Precision safety tip facilitates navigation of curved and calcified canals
Premium, uncompromised quality:
– Compression-fit handle (allows for apex locator readings)
– Clear calibration markings
– Sharp cutting flutes
– Consistent sizing
– Precision safety tip (not blunt or pointed, which can lead to ledging)
– Sterile blister packaging

EndoSequence Scout Files are provided in sterile blister packs with four instruments per pack. We have packaged and priced these instruments with the endodontist in mind. A single-use policy is suggested thereby preventing cross contamination and maximizing patient safety and office efficiency.
• 300-500 RPM/.6-2 Ncm Torque
• Use a light touch cleaning the flutes frequently (at least after every 3 engagements).
• Use as a stand-alone system with a crown-down or step-back technique or as a blended technique with other master files.
NiTi FILE SYSTEMS 14 Robust Cross Section Precision Safety Tip Reduced Maximum Flute Diameter Calibration Markings Proprietary Heat-Treated NiTi Tip Size ID Taper ID
File/ Tip ID Tip Size .04 Taper .06 Taper 21 mm 25 mm 21 mm 25 mm White 15 5026685U0 5026691U0 – –Purple 17 5026686U0 5026692U0 5027474U0 5027480U0 Yellow 20 5026687U0 5026693U0 5027475U0 5027481U0 Red 25 5026688U0 5026694U0 5027476U0 5027482U0 Blue 30 5026689U0 5026695U0 5027477U0 5027483U0 Green 35 5026690U0 5026696U0 5027478U0 5027484U0 Black 40 5027104U0 5027105U0 5027479U0 5027485U0 White 45 5027106U0 5027107U0 5027599U0 5027600U0
Individual Packs (4/Pack) Torque Setting: .6-2Ncm Speed Setting: 300-500 RPM (curved); 900 RPM (calcified)
SCOUT FILES
ENDOSEQUENCE® SCOUT FILES PRODUCT OFFERING STERILE R
ENDOSEQUENCE®
TECHNIQUE
EndoSequence® Scout Files
At a glance the below NiTi instruments look fairly similar, but closer inspection reveals significant differences. These un-retouched, highmagnification images of unused instruments highlight what can be verified clinically:
ENDOSEQUENCE® SCOUT FILES
HANDLE
Compression-fit; apex locator compatible



STOPPER Sturdy; snug; does not wobble; stays in place


CALIBRATION MARKINGS
Clearly visible
PACKAGING
Sterile blister packs
STERILE R
COMPETITOR A COMPETITOR B
HANDLE
Glued handle; not apex locator compatible
STOPPER Thin; wobbly; does not stay in place

CALIBRATION MARKINGS
Not clearly visible
PACKAGING Plastic boxes
Magnification: 90x
CUTTING FLUTES
Clean, sharp cutting edges
TIP
Precision safety; guides around curves
Magnification: 90x
CUTTING FLUTES
Machine grinding evident
TIP
Blunt (left) or pointed (right)
NiTi FILE SYSTEMS US : Shop.BrasselerUSA.com or 800.841.4522 | Canada : Shop.Brasseler.ca or 800.363.3838 15
EndoSequence® VT Scout Files
EndoSequence VT Scout Files feature a proprietary variable tapered design that allows for deep apical shaping while preserving coronal tooth structure. This design is comparable to the V Taper™ 2 file, previously sold by SS White®. Minor design upgrades include a short 16mm compression-fit nickel handle and a more robust stopper. These heat-treated NiTi files are extremely resistant to cyclic fatigue and are preferred by clinicians that embrace a minimally invasive shaping philosophy.

There has been a paradigm shift in endodontics in which canal preparations have been transitioning from larger flared shapes to less invasive shapes, especially in the coronal third. This change has coincided with the introduction of advanced irrigation systems and nonshrinking, bonded bioceramic sealer, such as EndoSequence BC Sealer™. EndoSequence VT Scout files feature a maximum flute diameter (MFD) which is extremely conservative. However, the tip portion is designed to provide an optimal “deep apical shape”, which helps to facilitate proper irrigation and obturation.
ENDOSEQUENCE® VT SCOUT FILES PRODUCT OFFERING
Individual Packs (4/Pack)
Max. Diameter of Other Popular NiTi Systems
NiTi FILE SYSTEMS 16 File/Tip ID Tip Size 17 mm Orifice Shaper 21 mm 25 mm Band Stopper Purple Green 13 - 5028563U0 5028568U0 White Yellow 14 - 5028564U0 5028569U0 White Gray 17 - 5028565U0 5028570U0 Yellow Black 20 - 5028566U0 5028571U0 Red Black 25 - 5028567U0 5028572U0 Clear N/A 25 5028573U0 -Assortment (5/Pack) 13-25 - 5029121U0 5029122U0 Variable
Parabolic
Cross-Section Tip Size D5 MFD 0.13 0.28 0.48 0.14 0.29 0.56 0.17 0.35 0.55 0.2 0.47 0.7 0.25 0.52 0.75 ProTaper Ultimate™ MFD Slider .99 Shaper 1.0 Vortex Blue™ MFD 20/.04 0.84 25/.04 0.89 Taper ID
taper design provides a deep apical shape with
Cross-Section
V-Taper™ is a trademark of EdgeEndo®. SS White® is a registered trademark of SS White Dental, Inc. ProTaper Ultimate™ and Vortex Blue® are trademarks of Dentsply Sirona, Inc. GentleWave® is a registered trademark of Sonendo, Inc.
EndoSequence® VT Scout Files

CASE STUDIES
The EndoSequence VT Scout Files provide a conservative coronal preparation with the deep apical shape that I prefer. The files allow me to confidently navigate extremely tight and curved canals with ease.





NiTi FILE SYSTEMS US : Shop.BrasselerUSA.com or 800.841.4522 | Canada : Shop.Brasseler.ca or 800.363.3838 17
Adam Davis, DDS Cumberland Endodontics
Dr. Tom McClammy D.M.D., M.S. North Scottsdale Endodontics & Implantology Scottsdale, AZ
Pre-op radiograph/ treatment planning
Case shaped with VT Scout Files followed by GentleWave® and obturated with BC Sealer HiFlow
Canals shaped conservatively with VT Scout 14/03, 17/04 and finished with EndoSequence® CM 20/04
Case obturated with EndoSequence® BC Sealer HiFlow™ and MF gutta percha
“ “
“
At Cumberland Endodontics, dentin preservation and efficiency are always top of mind. These files allow me to predictably treat difficult cases, preserve dentin, and provide the best outcome for our patients.
“
GentleWave® is a registered trademark of Sonendo, Inc.
ESR™ CM EndoSequence® Controlled Memory Reciprocating Files
ESR utilizes the latest NiTi technology to provide clinicians with superior safety, efficiency and performance. ESR files are also designed to preserve more coronal tooth structure compared to WaveOne® Gold.
• Reverse-cutting flute design: cuts on the counter-clockwise motion
• Compatible with EndoSync™ Plus, ProMark®, e3® and NLZ™ E electric motors
• Available in #15 (Scout), #25, #30, #40 and #50
• Heat treated NiTi allows for pre-bending
• Constant taper design
• Sterile blister packs of three instruments

STERILE R
ESR CM features a similar but more flexible flute design*

*63% of evaluators noted that ESR CM is more flexible than WaveOne® Gold in an internal clinical survey.
• ESR CM features a size #30 which is less invasive than the WaveOne® Gold primary file

• ESR CM can be autoclaved if sterility is compromised
ESR CM features a novel safety tip optimized for reciprocation
NiTi FILE SYSTEMS 18 Diameter (mm) Distance From Tip (mm) .94 Diameter (mm) Distance From Tip (mm) D16 .74 .42 D11 D3 D16 1.18 D11 D3 .95 .47 Safety Guiding Tip Reverse Cutting Flute Design Calibration Markings Proprietary Heat-Treated NiTi
WaveOne® Gold #25 Primary ESR CM #30 Taper ID Modified Triangular Cross-Section
Rectangular Cross-Section
Triangular Cross-Section
Modified
Modified
NLZ™ is a trademark of Nakanishi, Inc.
WaveOne®, ProMark® and e3® are registered trademarks of Dentsply Sirona, Inc.
ESR™ CM VS. WAVEONE® GOLD
ESR™ CM EndoSequence® Controlled Memory Reciprocating Files



1. After straight line access, determine working length (WL) with a size #10 K-file. In extremely tight canals consider establishing glidepath to WL with the ESR CM #15C Scout file.
2. Use the ESR CM #25 primary/gauging file to estimate the canal size by engaging in three light strokes.
a. If the file reaches the apex easily the canal is “Basic” (larger) and you should finish with the Large ESR CM #40 or Extra-Large ESR CM #50 file.
b. If the ESR CM #25 does not reach the apex after two series of three light strokes the canal is “Advanced” (tighter) and you need to use a #15 K-file or the ESR CM #15C Scout file to reestablish a safe glidepath to WL. Next, finish with an ESR CM #30 (which actually has a smaller max diameter than the #25). For extremely tight canals consider finishing with the Small ESR CM #20.
3. Obturate with BC Sealer™ and the matching BC Points™ for the last file used to reach WL.




*Summarized technique as taught by Real World Endo®. See IFU for complete instructions.
ESR CM files are provided in sterile blister packs for optimal convenience and safety. If sterility is compromised prior to treatment the files can be sterilized without any loss of functionality or performance.

NiTi FILE SYSTEMS US : Shop.BrasselerUSA.com or 800.841.4522 | Canada : Shop.Brasseler.ca or 800.363.3838 19
File/Tip ID Tip Size 21 mm 25 mm 31 mm White 15C 5029334U0 5029335U0 5029336U0 Yellow 20 5029126U0 5029127U0 5029128U0 Red 25 5028078U0 5028086U0 5028094U0 Blue 30 5028079U0 5028087U0 5028095U0 Black 40 5028081U0 5028089U0 5028097U0 Yellow 50 5028082U0 5028090U0 5028098U0
ESR™ CM TECHNIQUE*
ESR™ CM PRODUCT OFFERING Individual Packs (3/Pack) ESR™ CM #25/.06 #10 K-File to WL 500 rpm/.2 Ncm Motion: Memory #3 (CCW 180o/CW 60o) ESR™ CM #50/.04 XL ESR™ CM #40/.04 L Primary/Gauging ESR™ CM #20/.04 S ESR™ CM #30/.04 M ESR™ CM Scout #15C/.04
ESR™ EndoSequence® Reciprocating Files



ESR utilizes the latest NiTi technology to provide clinicians with superior safety, efficiency and performance. ESR files are also designed to preserve more coronal tooth structure compared to WaveOne® Gold.
Similarities
Reverse-cutting flute design: cuts on the counter-clockwise motion (Fig. 1)
• Compatible with EndoSync™ Plus, ProMark®, e3® and NLZ™ E electric motors (reciprocating range of motion: 150°CCW/30°CW - 170°CCW/50°CW)
• Available in #20 (small), #25 (primary), #35 (medium), #45 (large) and #17 (scouting file)
Heat treated NiTi allows for pre-bending
• Progressive taper design (Fig. 2)

Sterile blister packs of three instruments
STERILE R
ESR Advantages
• ESR features a similar but more conservative design (Fig. 3 & 4)
• Smoother cutting/less chatter ESR is more cost effective
ESR can be autoclaved if sterility is compromised
NiTi FILE SYSTEMS 20
NLZ™ is a trademark of Nakanishi, Inc. WaveOne®, ProMark® and e3® are registered trademarks of Dentsply Sirona, Inc. 11-16 .046 Distance From Tip (mm) Diameter (mm) Diameter (mm) Distance From Tip (mm)
3
4
Fig. 1 Distance From Tip (mm) #25 ESR ™ #25 WaveOne ® Gold Taper 1.04 16 16 1.12 .73 9 9 .84 7-11 .066 3-7 .059 0-3 .076 ESR™
Fig.
Fig.
Fig. 2
VS. WAVEONE® GOLD
Progressive Rectangular Cross Section Safety Guiding Tip Black
(Allows
Apex Locator Readings) Reverse
Flute
Calibration Markings Proprietary Heat-Treated NiTi Speed Setting: 300-350 RPM
Compression Fit Handle
for
Cutting
Design
ESR™ EndoSequence® Reciprocating Files

ESR™ TECHNIQUE
1. Establish Working Length (WL) with a #10 K-File.
2. Start with ESR #25 Primary File. Use two series of Rhythm Motions. Rhythm Motion = three light strokes to engagement, remove file and clean flutes of debris, reirrigate

3. If Primary File (#25) reaches WL easily, finish with a larger file (#35 or #45). If not, finish with a smaller file (#20).
4. Obturate with matching ESR™ BC Points™ and EndoSequence® BC Sealer™
ESR
File (Optional/Extra-Tight Canals)
Individual Packs (3/Pack)
ESR files are provided in sterile blister packs for optimal convenience and safety. If sterility is compromised prior to treatment the files can be sterilized without any loss of functionality or performance.





NiTi FILE SYSTEMS US : Shop.BrasselerUSA.com or 800.841.4522 | Canada : Shop.Brasseler.ca or 800.363.3838 21
PRODUCT OFFERING File/Tip ID Tip Size 21 mm 25 mm 31 mm Purple 17 5026662U0 5026667U0 5026672U0 Yellow 20 5026663U0 5026668U0 5026673U0 Red 25 5026664U0 5026669U0 5026674U0 Green 35 5026665U0 5026670U0 5026675U0 White 45 5026666U0 5026671U0 5026676U0
ESR™
ESR #20 (Small)
#17 Scout
ESR #25 (Primary)
ESR #35 (Medium)
ESR #45 (Large) #10 to WL
XP-3D addresses the shortcomings of traditional NiTi instrumentation and ushers in a new biologic standard of care in endodonti c instrumentation.


Conventional NiTi files can only create round shapes, forcing clinicians to choose between underpreparation or overpreparation of the canal. XP-3D adapts to the canal and cleans three-dimensionally with very low stress to the instrument and the dentin:


canal (area to be cleaned)
The patented XP-3D Shaper safely, efficiently and effectively cleans the root canal system three-dimensionally while respecting the canal anatomy. As it rotates, the instrument’s orbit expands and contracts to abrade the broad and narrow aspects of the canal equally. This intuitive micro mechanical debridement allows the practitioner to utilize a single instrument to safely and efficiently clean and enlarge the canal while respecting the original canal morphology.
Like the XP-3D Shaper, the XP-3D Finisher utilizes Brasseler’s exclusive MaxWire Technology to adapt to the canal’s natural anatomy. The XP-3D Finisher has a bowed shape at body temperature and is incredibly flexible. The instrument debrides the root canal system threedimensionally and allows for enhanced irrigation. Unlike the XP-3D Shaper, the XP-3D Finisher is intended to clean a prepared canal and will not change the shape once prepared.
NiTi FILE SYSTEMS 22 File/Tip ID Tip Size 21 mm (Stopper) 25 mm (Stopper) 31 mm (Stopper) Blue 30 5025897U0 5028598U0 5028599U0 Patent Pending
File/Tip ID Tip Size 21 mm (Stopper) 25 mm (Stopper) Red 25 5025842U0 5024933U0 Blue 30 5025844U0 5025843U0
XP-3D Finisher (3/Pack) The
Dentin Area cleaned Anatomically Prepared Canal Underprepared Canal Overprepared Canal Weakened dentin TRADITIONAL FILES XP-3D
XP-3D™ XP-3D Shaper (3/Pack)
THE MAXWIRE® EFFECT
Featuring Brasseler’s exclusive MaxWire® Technology, XP-3D adapts to the canal’s natural anatomy by expanding once exposed to body temperature.
• Super elasticity, extreme flexibility and resistance to cyclic fatigue
• Transformation to a robust, predefined serpentine shape at body temperature 95°F (35°C)
• Ability to gently expand to the natural anatomy of the root canal

68°F (20°C) M-PHASE Martensitic Phase
At or below room temperature the instrument is very malleable and has a relaxed serpentine shape.





Soft Shape
95°F (35°C) A-PHASE Austenitic Phase
When introduced to warmer temperatures (>95°F), the instrument transitions to a more robust serpentine shape.
Memorized Shape
THE ULTIMATE RETREATMENT INSTRUMENT
and
are excellent for retreatment. For optimal results, use at 1,500 RPM.
NiTi FILE SYSTEMS US : Shop.BrasselerUSA.com or 800.841.4522 | Canada : Shop.Brasseler.ca or 800.363.3838 23
The XP-3D Shaper
XP-3D Finisher R (#30)
Patent Pending
Images courtesy of Dr. Klaus Lauterbach, Germany
XP-3D™
EndoSequence® Precision Endodontic System

EndoSequence is the first endodontic system to be fully synchronized from instrumentation through obturation and post placement. The constant tapered EndoSequence rotary files contain many patented features which provide unparalleled efficiency and safety. The EndoSequence BC Points and Fiber Posts are laser verified to precisely match the shape (tip/taper) created by the files and the system utilizes the revolutionary, award winning BC Sealer. Join the thousands of others that have discovered the host of benefits that EndoSequence brings to their practice!
THE PATENTED ENDOSEQUENCE FILE DESIGN
EndoSequence is the only file in the world that contains all of the following features:
PATENTED ACP (ALTERNATING CONTACT POINT™) DESIGN Non-landed, reduced-drag design


Centers file within canal without radial lands
Prevents self-threading “screw in” to canal Enhances debris removal


Maximizes cutting efficiency
ELECTROPOLISHED SURFACE
Eliminates surface imperfections that weaken other files
Increases file sharpness
AVAILABLE WITH CALIBRATION MARKINGS Visible on radiographs EndoSequence File
Typical Competitve File
PROCEDURE PACKS
Canal Size
NO RADIAL LANDS
Flexibility is maximized
Torque is minimized
Reduced cross section thickness

Sharp cutting edge
PRECISION TIP
Non-active at the tip, fully active precisely at 1mm
NiTi FILE SYSTEMS 24
3 point engagement 2 point engagement 1 point engagement No engagement
Large Large Small Medium Medium Small 2013 READERS’ CHOICE AWARD
EndoSequence® Rotary Files



Individual Packs (4/Pack)
Assorted Procedure Packs
Individual Packs - Calibrated (4/Pack)
Note: See Obturation section for matching gutta percha and paper points

NiTi FILE SYSTEMS US : Shop.BrasselerUSA.com or 800.841.4522 | Canada : Shop.Brasseler.ca or 800.363.3838 25 Tip Size 21 mm 25 mm 19 mm 19 mm 21 mm 20 mm 20 mm 22 mm Taper
File/Tip ID Tip Size .04 Taper .06 Taper 08 Taper 21 mm 25 mm 31 mm 21 mm 25 mm 31 mm 16 mm Orange 27 5008966U0 - - - - - –White 15 5008967U0 5008981U0 5008995U0 5008973U0 5008987U0 5009001U0Yellow 20 5008968U0 5008982U0 5008996U0 5008974U0 5008988U0 5009002U0 5027183U0* Red 25 5008969U0 5008983U0 5008997U0 5008975U0 5008989U0 5009003U0Blue 30 5008970U0 5008984U0 5008998U0 5008976U0 5008990U0 5009004U0Green 35 5008971U0 5008985U0 5008999U0 5013140U0 5011647U0 5013147U0Black 40 5008972U0 5008986U0 5009000U0 5013141U0 5013144U0 5013148U0White 45 5011831U0 5011836U0 5011841U0 5013142U0 5013145U0 5013149U0Yellow 50 5011832U0 5011837U0 5011842U0 5013143U0 5013146U0 5013150U0Red 55 5011833U0 5011838U0 5011843U0 - - -Blue 60 5011834U0 5011839U0 5011844U0 - - -Green 70 5014388U0 5014389U0 5014390U0 - - -Black 80 5014391U0 5014392U0 5014393U0 - - -File/Tip ID Tip Size .04 Taper .06 Taper 21 mm 25 mm 21 mm 25 mm White 15 5019101U0 5019113U0 5019153U0 5019161U0 Yellow 20 5019102U0 5019114U0 5019154U0 5019162U0 Red 25 5019103U0 5019115U0 5019155U0 5019163U0 Blue 30 5019104U0 5019116U0 5019156U0 5019164U0 Green 35 5019105U0 5019117U0 5019157U0 5019165U0 Black 40 5019106U0 5019118U0 5019158U0 5019166U0 White 45 5019107U0 5019119U0 5019159U0 5019167U0 Yellow 50 5019108U0 5019120U0 5019160U0 5019168U0 Red 55 5019109U0 5019121U0 -Blue 60 5019110U0 5019122U0 -Green 70 5019111U0 5019123U0 -Black 80 5019112U0 5019124U0 -File/Tip ID Tip Size .04 Taper .06 Taper 21 mm 25 mm 31 mm 21 mm 25 mm 31 mm Small 30-15 5009009U0 5009010U0 5009011U0 5009015U0 5009016U0 5009017U0 Medium 40-25 5009012U0 5009013U0 5009014U0 5013151U0 5013152U0 5013153U0 Large 50-35 5014382U0 5014383U0 5014384U0 5013154U0 5013155U0 5013156U0 Extra-Large 55-80 5014385U0 5014386U0 5014387U0 - - -
Torque Setting: 1.8 - 2.3 Ncm Speed Setting: 500 - 600 RPM *Orifice Shaper
The restoration of an endodontically treated tooth begins at the apex. The cleaning and shaping instruments should be minimally invasive and preserve the structural integrity of the tooth.
• The obturation materials should bond to the root canal walls, thereby strengthening the root. When a post is necessary, it should not put undue stress on the root. It should have a similar modulus of elasticity to that of dentin and it should match the shape created by the last instrument used to shape the canal.
• The system should be as safe and efficient as possible and every component should be designed to maximize the long term prognosis of the tooth.
ESX ® : TWO-FILE SHAPING SYSTEM RESPONSIBLE AND MINIMALLY INVASIVE





• Unlike other “simplified” file systems which utilize from one to three files, the ESX® system does not suggest that the practitioner finish specific canals to a pre-determined size. A "cookie cutter" approach can lead to under-and-over-preparation of canals.
• The ESX® system utilizes the Expeditor™ file (#15/.05) to help the practitioner select the appropriate final apical size for each canal based on its unique anatomy.
• Unlike other systems, the ESX® system is designed to preserve the maximum amount of coronal tooth structure, thereby maximizing the long-term prognosis of the tooth.
ESX
Use all ESX® files at 500-600 RPM with a torque setting of 1.5-2.3 Ncm.
• Use a “LIGHT TOUCH” and the "SINGLE STROKE AND CLEAN" technique. ESX® Expeditor™ File - Provides initial shaping and helps determine the appropriate finishing file for each canal using the following guidelines:
3 Significant engagement to obtain WL = Finish with ESX® Small File #25/.04*
3 Moderate engagement to obtain WL = Finish with ESX® Medium File #35/.04
3 Minimal engagement to obtain WL = Finish with ESX® Large File #45/.04
3 No engagement to obtain WL = Finish with ESX® Extra-Large File #55/.04
STEP
#25/.04
VIDEO TUTORIAL
Scan this QR code or visit RestorativeEndo.com for a step-by-step tutorial for the ESX® shaping and obturation technique.

STEP
engagement to WL = MEDIUM
#35/.04
#45/.04 #55/.04
* If ESX® Expeditor™ meets significant resistance consider utilizing the ESX® Scouting Files for initial glide path creation.
NiTi FILE SYSTEMS 26
® TECHNIQUE
ESX ® PHILOSOPHY
1 ESX®
To WL
Expeditor™ File
2 Final ESX® Finishing
To WL
File
ESX
ESX
ESX
Moderate
Significant
ESX
ESX®
engagement to WL = SMALL Minimal/no engagement to WL = LARGE / XL
#15/.05
ACCESSORY INSTRUMENTS
The standard ESX® System will successfully prepare the majority of cases. However, some cases (ie. highly calcified and/or severely curved canals) will benefit from the inclusion of one or more of the following specialty files. If the ESX® Expeditor™ meets significant resistance in obtaining working length, the ESX® Orifice Opener and/or ESX® Scouting Files should be utilized to obtain working length.
The Ultimate Orifice Shaper
ESX® 20/.08 (19 mm)



ESX® PRODUCT OFFERING
ESX® Scouting Files
ESX® 15/.02 & 15/.04
All ESX® instruments are sterile packaged in a clean room environment. Each instrument is individually blister packed and each blister is perforated.
Individual Packs (3/Pack)
QuicKit™ Assortment Packs (6/Pack)
The exclusive ESX® QuicKit™ provides the ideal tray setup for practitioners looking to maximize patient safety and simplify inventory management. The ESX® QuicKit™ contains a sterile #10 and #15 stiff K-file as well as the standard ESX® assortment.
NiTi FILE SYSTEMS US : Shop.BrasselerUSA.com or 800.841.4522 | Canada : Shop.Brasseler.ca or 800.363.3838 27
File/ Tip ID Tip Size .02 Taper .04 Taper .05 Taper .08 Taper 21 mm 25 mm 31 mm 21 mm 25 mm 31 mm 21 mm 25 mm 31 mm 19 mm White 15 5024150U0 5024152U0 – 5024151U0 5024153U0 – 5023991U0* 5023995U0* 5024099U0* –Yellow 20 – – – – – – – – – 5024291U0 Red 25 – – – 5023992U0 5023996U0 5024100U0 – – – –Blue 30 5024920U0 5024921U0 5024922U0 5024923U0 5024924U0 5024925U0 – – – –Green 35 – – – 5023993U0 5023997U0 5024101U0 – – – –Black 40 – – – 5024926U0 5024927U0 5024928U0 – – – –White 45 – – – 5023994U0 5023998U0 5024102U0 – – – –Red 55 – – – 5023989U0 5023990U0 5024103U0 – – – –File/ Tip ID Tip Size .02 Taper .04 Taper .05 Taper .02 Taper .04 Taper .05 Taper 21 mm 25 mm 5023987U0 5023988U0 Purple 10 1/PK – – 1/PK – –White 15 1/PK – – 1/PK – –White 15 – – 1/PK* – – 1/PK* Red 25 – 1/PK – – 1/PK –Green 35 – 1/PK – – 1/PK –White 45 – 1/PK – – 1/PK –* ESX® Expeditor™ * ESX® Expeditor™ STERILE R STERILE R ESX®
ScoutRaCe™
ScoutRaCe NiTi rotary files are designed for glide path management. The smaller tip and taper sizes allow practitioners to save time and effort by supplementing their hand filing. While ScoutRaCe files can be used for all cases they are particularly useful for tight, severely calicified or curved canals.
Torque Setting: N/A Speed Setting: 600 RPM (curved); 900 RPM (calcified)



Individual Packs (6/Pack)
Assortment Packs (5/Pack)
NiTi FILE SYSTEMS 28
File/Tip ID Tip Size .02 Taper .04 Taper .06 Taper .02 Taper .04 Taper .06 Taper 21 mm 25 mm 5020142U0 5020143U0 Purple 10 1/PK 1/PK 1/PK 1/PK 1/PK 1/PK White 15 1/PK - - 1/PK -Yellow 20 1/PK - - 1/PK - -
Triangular Cross Section ElectroPolishing Precision Safety Tip Alternating Cutting Edges (Centering Mechanism) Tip Size Taper File/Tip ID Tip Size .02 Taper .04 Taper .06 Taper 21 mm 25 mm 21 mm 25 mm 21 mm 25 mm Purple 10 5020144U0 5020147U0 5020145U0 5020148U0 5020146U0 5020149U0 White 15 5020154U0 5020155U0 - - -Yellow 20 5020156U0 5020157U0 - - - -
BioRaCe™
The BioRaCe Rotary File System is designed to help the practicioner safely and efficiently meet the biologically desirable apical sizes. The system utilizes a modified crown down technique, which varies both the tip size and the taper throughout the sequence. File stress and the subsequent probability of separation is limited because each file is only engaged in a third of the canal during use. Unlike other variable tapered systems, the bottom ~9-11 mm is a constant .04 taper, which expedites obturation.












Setting: 1.8 - 2.3 Ncm Speed Setting: 500 - 600 RPM









Individual & Assortment Packs (6/Pack)

NiTi FILE SYSTEMS US : Shop.BrasselerUSA.com or 800.841.4522 | Canada : Shop.Brasseler.ca or 800.363.3838 29
File/Tip ID File Name Tip Size Taper 19mm 21mm 25mm White BR0 25 .08 5020240U0 -Yellow BR1 15 .05 - 5020241U0 5020238U0 Red BR2 25 .04 - 5020242U0 5020239U0 Blue BR3 25 .06 - 5020247U0 5020246U0 Green BR4 35 .04 - 5019736U0 5019742U0 Black BR5 40 .04 - 5019737U0 5019743U0 Assortment BASIC SET BR0-BR5 BR0-BR5 - 5019732U0 5019734U0 Green BR4C 35 .02 - 5019738U0 5019744U0 Black BR5C 40 .02 - 5019739U0 5020139U0 Yellow BR6 50 .04 - 5019740U0 5020140U0 Blue BR7 60 .02 - 5019741U0 5020141U0 Assortment EXTENDED SET BR4C-BR7 BR4C-BR7 - 5019733U0 5019735U0
Triangular Cross Section ElectroPolishing Precision Safety Tip Alternating Cutting Edges (Centering Mechanism) Taper/Tip Size BR0 Coronal General Shaping Only 4 Gentle Strokes Clean After 4 Gentle Strokes / Instrument to WL Apical BR1 BR2 BR3 BR4 BR5 #25/.08 #15/.05 #25/.04 #25/.06 #35/.04 #40/.04 80 75 70 65 90 85 60 55 50 45 40 35 30 25 20 15 81 73 65 57 49 41 33 25 129 121 113 105 97 89 13 12 11 10 9 8 7 6 Canal Depth 5 4 3 2 1 0 77 73 69 65 85 81 61 57 53 49 45 41 37 33 29 25 85 81 79 75 93 89 71 67 63 59 55 51 47 43 39 35 92 88 84 80 100 96 78 72 68 64 60 56 52 48 44 40 103 97 91 85 115 109 79 73 67 61 55 49 43 37 31 25 8 mm 21 mm Zones of Contact Numbers represent le diameter (1/100 mm) 13 mm Torque
BT RaCe™
The unique, minimally invasive design of BT RaCe™ allows for the safe treatment of the majority of canals with just three instruments. Research has shown that the natural apical diameters of most roots are surprisingly large and often contain biofilm (in infected cases). Biofilm is up to 1,000 times more difficult to eliminate than floating planktonic microbes.* BT RaCe is designed to help the practitioner safely and efficiently meet the biologically desirable apical sizes without compromising coronal tooth structure, thereby maintaining the strength of the tooth. This unique shaping sequence, together with irrigation and bonded obturation, results in optimal endodontic success and survivability of the tooth.
*Source: Chávez de Paz L., JOE. Volume 33, Number 6, June 2007: 652-662.
BT RaCe Assortment Packs (3/Pack)
BT40 & BT50 Individual Packs (3/Pack)
When larger apical sizes are desired, utilize BT40 (#40/.04) and BT50 (#50/.04). These instruments are pre-sterilized and also contain the patented BT Tip allowing them to safely navigate curved canals despite their larger tip size.




BT RaCe QuicKit™ Assortment Packs (6/Pack)
The exclusive BT RaCe QuicKit provides the ideal tray setup for offices looking to maximize patient safety and simplify inventory management. The BT RaCe QuicKit contains a sterile #8, #10 and #15 RazorFlex file in addition to the standard BT RaCe assortment.
NiTi FILE SYSTEMS 30
File/Tip ID Tip Size .00 Taper .04 Taper .06 Taper .00 Taper .04 Taper .06 Taper 21 mm (Stopper) 25 mm (Stopper) 5024106U0 5024107U0 Purple 10 - - 1/PK - - 1/PK Green 35 1/PK - - 1/PK -Green 35 - 1/PK - - 1/PKFile/Tip ID Tip Size .00 Taper .02 Taper .04 Taper .06 Taper .00 Taper .02 Taper .04 Taper .06 Taper 21 mm (Stopper) 25 mm (Stopper) 5024104U0 5024105U0 Gray 08 - 1/PK - - - 1/PK -Purple 10 - 1/PK - - - 1/PK -White 15 - 1/PK - - - 1/PK -Purple 10 - - - 1/PK - - - 1/PK Green 35 1/PK - - - 1/PK - -Green 35 - - 1/PK - - - 1/PKFile/Tip ID Tip Size .04 Taper 21 mm (Stopper) 25 mm (Stopper) Black 40 5024108U0 5024109U0 Yellow 50 5024110U0 5024111U0
Triangular Cross Section ElectroPolishing Patented Booster Tip Alternating Cutting Edges (Centering Mechanism) Tip Size Taper Calibration Markings STERILE R
Torque Setting:
Speed Setting: 600 - 80,000 RPM
1.5Ncm
RaCe™
The RaCe NiTi Rotary File System utilizes a progressively smaller taper to ensure minimal file stress. The file contains the same patented features as BioRaCe and ScoutRaCe.



Individual Packs (5/Pack)
Assortment Pack (5/Pack)

NiTi FILE SYSTEMS US : Shop.BrasselerUSA.com or 800.841.4522 | Canada : Shop.Brasseler.ca or 800.363.3838 31
File/Tip ID Tip Size 0.10 Taper 0.08 Taper 0.06 Taper 0.04 Taper 0.02 Taper L1 = 19 mm L1 = 19 mm L1 = 19 mm L1 = 25 mm L1 = 25 mm L1 = 25 mm L1 = 25 mm L1 = 25 mm L1 = 25 mm L1 = 21 mm L2 = 8 mm L2 = 8 mm L2 = 9 mm L2 = 8 mm L2 = 16 mm L2 = 8 mm L2 = 16 mm L2 = 8 mm L2 = 16 mm L2 = 16 mm White 15 - - - - - - - - 5008667U0 5014972U0 Yellow 20 - - - - - - - - 5008771U0 5014973U0 Red 25 - 5008665U0 - 5008664U0 - 5008663U0 5008781U0 5008662U0 5008782U0 5014974U0 Blue 30 - - - - 5008765U0 - 5008766U0 - 5008770U0 5014975U0 Green 35 - - 5008764U0 - - - - - 5008668U0 5014976U0 Black 40 5008666U0 - - - - - - - 5008769U0 5014977U0 Yellow 50 - - - - - - - - 5008768U0 5014978U0 White 60 - - - - - - - - 5008767U0 5014979U0 File/Tip ID Tip Size 0.10 Taper 0.08 Taper 0.06 Taper 0.04 Taper 0.02 Taper L1 = 19 mm L1 = 19 mm L1 = 25 mm L1 = 25 mm L1 = 25 mm L2 = 8 mm L2 = 8 mm L2 = 8 mm L2 = 8 mm L2 = 8 mm 5008661U0 Red 25 - 1/PK 1/PK 1/PK 1/PK Black 40 1/PK - - -Total Length (L1) Working Length (L2) Triangular Cross Section ElectroPolishing Precision Safety Tip Alternating Cutting Edges (Centering Mechanism) Tip Size Taper Torque Setting: 1.8 - 2.3 Ncm Speed Setting: 500 - 600 RPM
RazorFlex files are manufactured with Brasseler’s exclusive Austenite NiTi alloy. The hardened NiTi and modified flute geometry deliver excellent cutting efficiency and torsional resistance. RazorFlex files are subjected to Brasseler’s extremely tight quality control standards and exhibit uncompromised performance. The extensive range of tip sizes and tapers allows you to quickly incorporate RazorFlex files into your treatment philosophy.
RAZORFLEX™ CLINICAL TIPS
· Always reach full working length to at least a #15/.02 prior to use of rotary files.
· Use a feather-light touch taking the file to engagement (not resistance).

· Use the Single Stroke and Clean Technique. Clean the flutes after each gentle engagement.
• Irrigate between each rotary file.
• Obturate the canals using BC Sealer™ and the corresponding BC Point™.
RAZORFLEX™ PRODUCT OFFERING

NiTi FILE SYSTEMS 32
File/ Tip ID Tip Size .04 Taper .05 Taper .06 Taper .08 Taper 21 mm 25 mm 21 mm 25 mm 21 mm 25 mm 19 mm White 15 5025131U0 5025138U0 Purple 17 5025146U0 5025147U0 Yellow 20 5025132U0 5025139U0 5025148U0 5025149U0 5025145U0 Red 25 5025133U0 5025140U0 5025150U0 5025151U0 Orange 27 5025152U0 Blue 30 5025134U0 5025141U0 5025155U0 5025159U0 Green 35 5025135U0 5025142U0 Black 40 5025136U0 5025143U0 White 45 5025137U0 5025144U0 Yellow 50 5025153U0 5025154U0 Modified Triangular Cross Section Precision Safety Tip Sharp Cutting Edges Enhanced Chip Space Tip Size ID Taper ID
Reference Markings
Torque Setting: 1.8 - 2.3 Ncm Speed Setting: 500 - 600 RPM
RazorFlex™
Individual Packs (4/Pack)
EndoSequence® Apical Verifiers
EndoSequence Apical Verifiers feature a unique reverse tapered design which allows the practitioner to safely navigate curved canals without the worry of separation. Another important feature of this design is that it allows you to verify and expand the apical diameter of roots without needlessly weakening the tooth. Use Apical Verifiers anytime that you want to confirm or increase the apical diameter of a canal without removing excessive radicular dentin.
Apical Verifiers (4/Pack)


Exceptionally Flexible Reverse Tapered Design
Torque Setting: .5 Ncm
NiTi FILE SYSTEMS US : Shop.BrasselerUSA.com or 800.841.4522 | Canada : Shop.Brasseler.ca or 800.363.3838 33
File/Tip ID Tip Size 21 mm 25 mm White 15 5018319U0 5018329U0 Yellow 20 5018320U0 5018330U0 Red 25 5018321U0 5018331U0 Blue 30 5018322U0 5018332U0 Assortment 15-30 5018327U0 5018337U0 Green 35 5018323U0 5018333U0 Black 40 5018324U0 5018334U0 Yellow 50 5018325U0 5018335U0 Blue 60 5018326U0 5018336U0 Assortment 35-60 5018328U0 5018338U0
Speed Setting: 500 - 600 RPM
Triton® All-in-One Irrigation Solution

Unlike traditional irrigants or other advanced 2:1 solutions, Triton works differently by avoiding the use of EDTA and CHX altogether. The non-NaOCl components in Triton proactively dissolve the dentinal debris allowing for a lower concentration of NaOCl to be exposed to organic debris without as much buffering. Synergistic and simultaneous dissolution of organic and inorganic debris permit the clinician to use lower volumes of irrigation solution and ensure maximum clinical efficiency.
Luer-activated valve
~8% NaOCl stored in one chamber and our proprietary blend of 14 chelating agents and surfactants in another, so you’ll always get a precise, freshly mixed dose
Mixing chamber is secured with one-way check valves, ensuring mixed solution can’t enter the storage chambers below
Order No. 5028425U0
EFFICIENT AND EFFECTIVE
By using a lower concentration of NaOCl and a patent-pending proprietary blend of surfactants and gentle chelating agents, Triton is the first irrigant to deliver all of the benefits of NaOCl, EDTA, and CHX in a single-step all-in-one irrigation solution.
NaOCl is rapidly neutralized upon contact with EDTA (and inorganic dentinal debris). Triton maintains an effective NaOCl concentration for organic tissue dissolution while simultaneously allowing for inorganic debris removal in just one step.
*Internal testing. Data on file.

IRRIGATION
LUBRICANT 34
&
4.5 4.0 3.5 3.0 2.5 2.0 1.5 1.0 0.5 0.0 0 0.5 0.25 1 1.5 2 2.5 3 %NaOCl Time (hrs) 3.9 3.7 3.5 3.1 3.0 2.6
Triton EDTA + NaOCl
Short-term Stability With NaOCl*
Pick-up Tubing
Triton® All-in-One Irrigation Solution
· Multi-functional single irrigation solution reduces chair time, procedural steps, and overall irrigation costs
· Simultaneous organic and inorganic debris removal
· Patent-pending composition allows for a lower concentration of NaOCl to be used while also delivering improved efficacy
· More effective at smear layer removal vs. NaOCl with EDTA
· Dissolves organic tissue up to 1.7x faster than traditional NaOCl


EFFECTIVE AGAINST E. FAECALIS BIOFILM




The efficacy of various irrigants against E. Faecalis biofilm was investigated both with and without dentin chips present. In the presence of dentin chips, only Triton was able eliminate all E. Faecalis.

MICROBES ARE SUSCEPTIBLE TO TRITON
Triton provided the largest zone of inhibition compared to 6% NaOCl and QMix®
KILLS MORE BACTERIA QUICKER
In an ex vivo evaluation of live versus dead bacteria comparing three different irrigation protocols, Triton was more effective than 6% NaOCl + 17% EDTA in half the time.
IRRIGATION & LUBRICANT US : Shop.BrasselerUSA.com or 800.841.4522 | Canada : Shop.Brasseler.ca or 800.363.3838 35
Xuyan Sheng, Zhejun Wang, Ya Shen (UBC)
Nelson Labs, Salt Lake City, UT. Study on file.
Ex Vivo Evaluation—Live vs. Dead Bacteria (Green=Live, Red=Dead) Water (3+3) min 6% NaOCl+17% EDTA (5+1) min Triton 3 min QMix® is a registered trademark of DENTSPLY International.
Triton 4% NaOCl 2%
17%
(control) Dead E. Faecalis Live E.
Ef cacy of Various Irrigants Against E. Faecalis Bio lm Under Different Conditons Without Dentin Chips With Dentin Chips
RESEARCH SUMMARY
CHX
EDTA Saline
Faecalis
Efficacy of Various Irrigants Against E. Faecalis Biofilm Under Different Conditions Antimicrobial Efficiency—Zone of Inhibition Control QMix® 6% NaOCl Triton
Dr. Karabucak, University of Pennsylvania, Dental Medicine Department of Endodontics (study in review)
Endo Solutions


Studies have shown that 15% of store bought NaOCl contains less than 1% available chlorine (which is needed for tissue dissolution and disinfection).* Brasseler USA's Endo Solutions adhere to strict FDA & ISO quality control measures.

*Quintessence Intl 2014;45:467-474; doi:10.3290/j.qi.a31805)
5% Sodium Hypochlorite
· Eliminates bacteria
· Used to irrigate during and after root canal debridement
17% EDTA
· Opens dentinal tubules
· Prepares dentin walls for obturation
· Removes smear layer
2% Chlorhexidine Gluconate
· Aids in post-op sensitivity
· Increases bond strength
Endo Solutions Irrigation Syringes
Luer-lock cap reduces cross-contamination and improves solution efficacy.



Brasseler USA’s irrigation syringes are ideal for surgical site irrigation and compatible with all luer-lock style needles and hubs. Disposable, non-sterile. Not for injection.


Irrigation Syringes (50/Pack)
3
6
Endo Solutions Irrigation Needles
Designed with a closed-end cannula and a side window dispersal point, Brasseler USA’s Irrigation Needles offer a unique design for unmatched effectiveness, patient comfort and safety in irrigating root canals.
Irrigation Needles (20/Pack)
IRRIGATION & LUBRICANT 36
Thickness 21 mm 27 mm 27 Gauge 5026557U0 5026558U0 31 Gauge 5026680U0 5026681U0 Volume Order No.
cc
5026555U0
cc
5026882U0
Volume Order No. 16 oz. 5026552U0 Volume Order No. 16 oz. 5026553U0 Volume Order No. 16 oz. 5026554U0 32 oz.* 5028445U0
*Bulk EDTA bottle does not have a luer-lock cap.
Endo Solutions Caddy

Features 3 forward-angled slots for standard Endo Solution bottles, 3 large base compartments and slots to accomodate up to 12 syringes (8 x 3cc & 4 x 6cc).
Contents not included with caddy
Order No.
5026556U0
EndoSequence® Lubricant
• Chelating agent
• Syringe and disposable tips make application and cleanup quick and easy
• Blue color provides reassurance that all of the EDTA has been removed prior to obturation
• Cream consistancy provides increased surface tension allowing the lubricant to better adhere to files
Active Ingredients:
EDTA: 15%
Urea Peroxide: 10%
Packaging Unit Order No.
Three 3g Syringes 5015119U0
EndoSequence® Canal Clean™


• Removes the smear layer
• Works in less than a minute
• Opens and cleans the dentinal tubules creating an optimal surface for endodontic sealers
• Low surface tension: surfactants allow Canal Clean to penetrate dentinal tubules and remove smear plugs


• Reduced EDTA forumla: prevents the undesired breakdown of dentin
Before Canal Clean After Canal Clean
Active Ingredients:
EDTA: 3%
Cocoamphodiacetate (surfactant)
Benzalkoniumchloride (anti-bacterial)
Packaging Unit Order No.
100 mL 5013409U0
250 mL 5013410U0
IRRIGATION & LUBRICANT US : Shop.BrasselerUSA.com or 800.841.4522 | Canada : Shop.Brasseler.ca or 800.363.3838 37
Bioactive Obturation Materials
YOUR TRUSTED LEADER IN BIOACTIVES...
Brasseler has revolutionized Endodontics and helped establish a new biologic standard of care in obturaiton. Consider the paradigm shift in restorative dentistry, moving from retentive form preparations with non-bonded amalgam to minimally invasive preparations with bonded composites. With the introduction of bioceramic bonded obturation, a similar paradigm shift has occurred in endo obturation. Because conventional sealers shrink and don’t bond to dentin, clinicians had to over-enlarge the canal to facilitate the placement and compaction of gutta percha to minimize the sealer interface. BC Sealer exhibits absolutely zero shrinkage and bonds to dentin through hydroxyapatite formation, allowing us to fully embrace minimally invasive shaping and cleaning protocols.
PULP CAPPING
• BC RRM on pulp
• BC Liner over BC RRM
RESORPTIVE DEFECT REPAIR

BC RRM Putty or Paste
Optional (case-based): BC Liner to cover the exposed unset BC RRM
ORIFICE BARRIER/LINER
• BC Liner
• Now available in blue
ROOT CANAL SEALING

• BC Sealer
INTRA-CANAL DRESSING
• BC Temp
PERFORATION REPAIR
BC RRM in site
Optional (case-based): BC Liner over BC RRM
RETROGRADE FILLING/APEXIFICATION
BC RRM Putty
Optional (case-based): BC RRM or BC Sealer syringed in site ahead of putty
OBTURATION MATERIALS 38
Bioactive Obturation Materials
ENDOSEQUENCE® BC SEALER™
• Premixed pure bioceramic
· The market’s leading sealer
· Biocompatible and antibacterial
Prefer warm obturation techniques?
Try BC Sealer HiFlow™!

ENDOSEQUENCE® BC TEMP™
Single or less frequent application
Highly biocompatible
Optimal pH
ENDOSEQUENCE® BC LINER™ (WHITE OR BLUE)




· RMGI optimized for use with BC Sealer/RRM
· Self-bonding and dual-cure
· Strong (241 mPA) and versatile
· Excellent for orifice barriers
ENDOSEQUENCE® BC RRM™
• Premixed pure bioceramic (flowable)
• Biocompatible and osteogenic
· Optimal for repairing sites difficult to reach with putty
ENDOSEQUENCE® BC RRM™
FAST-SET PUTTY
• Premixed pure bioceramic (condensable putty)
• Biocompatible and osteogenic
• Highly resistant to washout with optimal handling
OBTURATION MATERIALS Canada : Shop.Brasseler.ca or 800.363.3838 39
EndoSequence® BC Sealer™
Unlike conventional base/catalyst sealers, BC Sealer utilizes the moisture naturally present in the dentinal tubules to initiate its setting reaction. This highly radiopaque and hydrophilic sealer forms hydroxyapatite upon setting and chemically bonds to both dentin and to our bioceramic points (EndoSequence BC Points). BC Sealer is anti-bacterial during setting due to its highly alkaline pH and unlike traditional sealers, BC Sealer exhibits absolutely zero shrinkage!
EndoSequence® BC Sealer:
1 2g syringe




15 Intra-Canal Tips
1 Instructions for Use (IFU)
1 Safety Data Sheet (SDS)
Order No. 5017560U0
BIOCERAMIC BONDED OBTURATION

BC Sealer™ HiFlow™ is optimized for warm obturation techniques
EndoSequence® BC Sealer™ HiFlow™:
1.5g syringe

Intra-Canal Tips
Instructions for Use (IFU)
Safety Data Sheet (SDS)
Order No. 5026825U0
Standard gutta percha can be used with BC Sealer, but for a true, gap-free seal, BC Points are recommended. BC Points are impregnated and coated with bioceramic particles to allow for bonding with BC Sealer. The benefit of using BC Sealer and BC Points is that three-dimensional bonded obturation can be achieved at room temperature. However, if a warm vertical technique is preferred it is recommended to use BC Sealer HiFlow with BC Points 150 Series along with BC Pellets at 150ºC - 220ºC.
BC SEALER SETTING/BONDING REACTION
BC Sealer is a calcium silicate, calcium phosphate based sealer. The calcium silicate combines with water to form calcium hydroxide (high pH). The calcium hydroxide then combines with calcium phosphate to form hydroxyapatite.
OBTURATION MATERIALS 40
2013 READERS’ CHOICE AWARD
HYDRATION REACTIONS (A,B) 2[3CaO SiO2] + 6H2O → 3CaO 2SiO2 3H2O + 3Ca(OH)2 (A) 2[2CaO SiO2] + 4H2O → 3CaO 2SiO2 3H2O + Ca(OH)2 (B) PRECIPITATION REACTION 7Ca(OH)2 + 3Ca(H2PO4)2 → Ca10 (PO4)6 (OH)2 + 12H2O (C) HYDROXYAPATITE Qty/Pk Order No. 15 5027507U0 50 5028585U0 EndoSequence® Minimum Waste BC Tips 87% less waste vs. standard tips
EndoSequence® BC Sealer™


NEVER BEFORE HAS AN OBTURATION SYSTEM BEEN ABLE TO MAKE THESE CLAIMS.* HOW DOES YOUR CURRENT SYSTEM COMPARE?
*Research and other support materials available at www.BrasselerUSA.com/Bioceramics


BC Obturation Kit (.04 Taper):
1 BC Sealer
15 Intra-Canal Tips
1 Assorted BC Points Wheel (.04 Taper)
1 Instructions for Use (IFU)
1 Safety Data Sheet (SDS)
BC Obturation Kit (.06 Taper):
1 BC Sealer
15 Intra-Canal Tips

1 Assorted BC Points Wheel (.06 Taper)
1 Instructions for Use (IFU)
1 Safety Data Sheet (SDS)
Order No. 5019504U0 Order No. 5019505U0
OBTURATION MATERIALS US : Shop.BrasselerUSA.com or 800.841.4522 | Canada : Shop.Brasseler.ca or 800.363.3838 41
Radiograph courtesy of Dr. Gilberto Debelian, DMD, PhD, Adjunct Associate Professor, Dept of Endodontics at Universities of North Carolina and Pennsylvania
Micro CT Courtesy of Dr. Adam Lloyd, Chair of Department of Endodontics, UTHSC
and Points
System Biocompatible and Osteogenic 3 ? Chemical Bond of Sealer to Dentin 3 ? Chemical Bond of Sealer to Filling Material 3 ? Cost Effective (Considerably Less Expensive Than Carriers) 3 ? Highly Antibacterial (12+ pH upon setting) 3 ? Highly Radiopaque 3 ? Hydrophilic 3 ? Hydroxyapatite Producing 3 ? Ideal Working and Setting Time 3 ? User Friendly (Premixed Syringable Sealer) 3 ? Zero Shrinkage of Sealer and Filling Material 3 ? 3-D Bonded Obturation at Room Temperature 3 ?
BC Sealer
Your Current
EndoSequence® BC Points™ — Cold Bonded Obturation
BC Points™ (60/Pack)
Tip ID Tip Size .04 Taper .06 Taper
White 15 5019508U0 5019520U0
Yellow 20 5019509U0 5019521U0
Red 25 5019510U0 5019522U0
Blue 30 5019511U0 5019523U0
Green 35 5019512U0 5019524U0
Black 40 5019513U0 5019525U0
White 45 5019514U0 5019526U0
Yellow 50 5019515U0 5019527U0
Red 55 5019516U0 -
Blue 60 5019517U0 -
Green 70 5019518U0 -
Black 80 5019519U0 -
BC Obturation Wheel (.04 Taper):
15 ea. (sizes 15-60) BC Points (.04 Taper) 15 ea. (sizes 15-60) Paper Points (.04 Taper)
BC Obturation Wheel (.06 Taper): 15 ea. (sizes 15-50) BC Points (.06 Taper)
ea. (sizes 15-50) Paper Points (.06 Taper)
EndoSequence® BC Points™ & Pellets™ — Warm Bonded Obturation



150 Series BC Points™ (60/Pack)
Stiffer to drive sealer Melt at 150°C
ESR™ BC Points™ (60/Pack)
CM Taper™ BC Points™ (60/Pack)
Tip ID Tip Size .04 Taper
Tip ID Tip Size Order No.
Tip ID Tip Size Order No.
Scout BC Points™ (60/Pack)
Tip ID Tip Size .04 Taper White 15 5027194U0 Yellow 20 5027195U0 Red 25 5027196U0 Blue 30 5027197U0 Green 35 5027198U0
Black 40 5027199U0 White 45 5027200U0
BC Pellets™ (100/Pack)
Melt at 150°C
Order No. 5023074U0
Build a complete warm obturation arsenal with the EndoPro 270 ™ (pg. 59) and BC Sealer™ HiFlow™ (pg. 40).

OBTURATION MATERIALS 42
20 5024584U0 Red 25 5024585U0 Blue 30 5024586U0 Green 35 5024587U0 Black 40 5024588U0 White 45 5024589U0 Red 55 5024590U0
White 15 5024583U0 Yellow
Yellow
5026705U0 Red 25 5026706U0 Green 35 5026707U0 White 45 5026708U0 Assortment 20-45 5026813U0
20
15
Order
5019506U0 Order
5019507U0
No.
No.
Yellow
Blue
Assortment F1-F4
F1 5028547U0 Red F2 5028548U0
F3 5028549U0 Black F4 5028550U0
5028551U0
EndoSequence® Gutta Percha & Paper Points
• Designed to precisely match the constant tapered preparation created by the EndoSequence file (.04, .06)
• Exhibit extremely tight quality assurance tolerances
• Calibration markings for quick and accurate depth measurements
• Undergo a proprietary stiffening process
Stiffer than normal gutta percha
Calibrated depth markings at 17, 19 20, 21, 23 and 25 mm
Laser verified for tip and taper accuracy
Gutta
Percha Points (60/Pack)
Calibrated depth markings at 19 20, 21, 23 and 25 mm
ISO tip size
Paper Points (90/Pack)
Tip ID Tip Size .04 Taper .06 Taper

EndoSequence® Obturation Wheel (.04 Taper): 15 ea. (sizes 15-60) Gutta Percha Points (.04 Taper) 15 ea. (sizes 15-60) Paper Points (.04 Taper)
Order No. 5017989U0
EndoSequence® Obturation Wheel (.06 Taper): 15 ea. (sizes 15-50) Gutta Percha Points (.06 Taper) 15 ea. (sizes 15-50) Paper Points (.06 Taper)
Order No. 5017990U0

OBTURATION MATERIALS US : Shop.BrasselerUSA.com or 800.841.4522 | Canada : Shop.Brasseler.ca or 800.363.3838 43
White 15 5017949U0 5017961U0 Yellow 20 5017950U0 5017962U0 Red 25 5017951U0 5017963U0 Blue 30 5017952U0 5017964U0 Green 35 5017953U0 5017965U0 Black 40 5017954U0 5017966U0 White 45 5017955U0 5017967U0 Yellow 50 5017956U0 5017968U0 Red 55 5017957U0Blue 60 5017958U0Green 70 5017959U0Black 80 5017960U0 -
ID Tip Size
Taper .06 Taper White 15 5017969U0 5017981U0 Yellow 20 5017970U0 5017982U0 Red 25 5017971U0 5017983U0 Blue 30 5017972U0 5017984U0 Green 35 5017973U0 5017985U0 Black 40 5017974U0 5017986U0 White 45 5017975U0 5017987U0 Yellow 50 5017976U0 5017988U0 Red 55 5017977U0Blue 60 5017978U0Green 70 5017979U0Black 80 5017980U0 -
Tip
.04
Activ GP™ Sealer

The unique benifits of a modified glass ionomer sealer:
• Ideal for single visit RCT and post and core (15 minute working time)
• Excellent biocompatibility
• Bonded obturation
• Highly radiopaque
Activ GP™ Points
Activ GP Points exhibit all of the same characteristics of our BC Points, but they are coated and impregnated with glass ionomer particles for optimal bonding with ActivGP Sealer. Another distinguishing feature is that Activ GP Points contain calibration (depth) markings.


Individual Packs (60/Pack)
ID Tip Size .04 Taper .06 Taper
Calibrated depth markings at 17, 19 20, 21, 23 and 25 mm

Stiffer than normal gutta percha
Laser verified for tip and taper accuracy
ISO tip size
Impregnated and coated with glass ionomer particles
Activ GP™ Obturation Wheel (.04 Taper):
15 ea. (sizes 15-60) Activ GP Points (.04 Taper)

15 ea. (sizes 15-60) Paper Points (.04 Taper)
Order No. 5017991U0
Activ GP™ Obturation Wheel (.06 Taper):
15 ea. (sizes 15-50) Activ GP Points (.06 Taper)
15 ea. (sizes 15-50) Paper Points (.06 Taper)
Order No. 5017992U0
OBTURATION MATERIALS 44
White 15 5017993U0 5018005U0 Yellow 20 5017994U0 5018006U0 Red 25 5017995U0 5018007U0 Blue 30 5017996U0 5018008U0 Green 35 5017997U0 5018009U0 Black 40 5017998U0 5018010U0 White 45 5017999U0 5018011U0 Yellow 50 5018000U0 5018012U0 Red 55 5018001U0Blue
5018002U0
Green 70 5018003U0
Black
5018004U0
Tip
60
-
-
80
-
Liquid Powder
Order No. 5011494U0
Order No. 5011493U0
Activ GP Point Canal Wall Activ GP Sealer
Standard & Accessory Gutta Percha
Standard Gutta Percha (120/Pack)
• .02 taper
• Used for lateral or vertical condensation
Gutta Percha Accessories (100/Pack)

Used in conjunction with larger cones for lateral or vertical condensation
Finger Spreaders & Finger Pluggers
• Spreaders are used for lateral condensation; Pluggers are used for vertical condensation
• Manufactured of high quality stainless steel
• Ideal combination of strength and flexibility
• For added flexibility, use our NiTi Spreaders
Finger Spreaders (6/Pack)
Paste Fillers
EndoSequence® BC Paste Fillers (4/Pack)
• Unique handle can be used with all latch type contra-angle handpieces on the market

• Exclusive automatic safety clutch for stress-free work
Tip Size 30 mm
XF 5009233U0
FF 5009235U0
MF 5009238U0
F 5009234U0
FM 5009236U0
M 5009237U0
Finger Pluggers - Stainless Steel (6/Pack)
5027827U0
Paste Fillers (4/Pack)
• Used in low speed latch type handpieces
• Precision spirals deliver sealers, cements and medicaments evenly throughout the canal
Tip ID Tip Size 21 mm 25 mm
Red 25 5014473U0 5014477U0
Blue 30 5014474U0 5014478U0
Green 35 5014475U0 5014479U0
Black 40 5014476U0 5014480U0
OBTURATION MATERIALS US : Shop.BrasselerUSA.com or 800.841.4522 | Canada : Shop.Brasseler.ca or 800.363.3838 45
Yellow
5009240U0 Red 25 5009241U0 Blue 30 5009242U0 Green 35 5009243U0 Black 40 5009244U0 White 45 5009245U0 Yellow 50 5009246U0 Red 55 5009247U0 Blue 60 5009248U0 Green 70 5009249U0 Black 80 5009250U0 Assortment 15-40 5009251U0
Stainless
White 15
5007087U0 Yellow 20 5007074U0 5007088U0 Red 25 5007075U0 5007089U0 Blue 30 5007076U0 5007090U0 Green 35 5007077U0 5007091U0 Black 40 5007078U0 5007092U0 Assortment 15-40 5007079U0 5007093U0 Tip ID Tip Size 25 mm White 15Yellow 20Red 25 5007082U0 Blue 30 5007083U0 Green 35
Black 40
Assortment 15-40 5007086U0
Red 25 5027822U0 5027825U0 Blue 30 5027823U0 5027826U0 Green 35 5027824U0
Tip ID Tip Size 30 mm White 15 5009239U0
20
Tip ID Tip Size 25 mm
Steel NiTi
-
-
-
Tip ID Tip Size 21 mm 25 mm
EndoSequence® BC Temp™
BC Temp is a premixed bioceramic paste for intracanal dressing. Unlike traditional Calcium Hydroxide pastes, the primary components of BC Temp are Calcium Silicates and Calcium Oxide which combine with the water naturally present in dentin to produce Calcium Hydroxide which dissociates into Ca2+ and OH-. The hydroxyl ions (OH-) released are responsible for a significant increase in the pH of the surrounding tissues, making the environment unsuitable for bacterial growth. The hydration reaction of Calcium Silicates allows BC Temp to have a gradual and slow release of calcium and hydroxyl ions which eliminates the need for frequent applications.
Single or less frequent application
Highly biocompatible
Optimal pH
Easily removed
High radiopacity
Non-staining
Optimal flow – 23,85 ± 0,33 mm


EndoSequence® BC Temp™:

4 .5g Syringes
20 Delivery Tips
1 Safety Data Sheet (SDS)
Order No. 5027169U0
BC Temp is highly radiopaque (>9mm) and utilizes Calcium Tungstate as a radiopacifier so it is non staining and unlike conventional Calcium Hydroxide materials, BC Temp is easily removed which reduces chair time.
OBTURATION
46
MATERIALS
Initial X-Ray Radiograph after initial placement of BC Temp Final X-Ray Final obturation; 15 days after initial placement of BC Temp
Images courtesy of Dr. Kely F. Bruno Universidade Federal de Goiás, Goiânia, GO, Brazil
EndoSequence® BC Temp™
WHY UPGRADE TO BC TEMP?
GRADUAL AND SUSTAINED RELEASE OF BOTH HYDROXYL AND CALCIUM IONS
BC Temp is composed of calcium silicates and calcium oxide, which create Ca(OH)2 when exposed to moisture in the root canal. BC Temp has three different crystalline structures, each with a distinct rate of hydration: This gradual/staged release eliminates the need for frequent applications. Traditional intracanal dressings start as Ca(OH)2 and have a larger particle size, which leads to faster disassociation of calcium and hydroxyl ions. Furthermore, BC Temp’s unique formulation releases more calcium ions than traditional Ca(OH)2, which makes it more effective at hard tissue formation and faster healing of periapical lesions.*
Mean ± standard deviation for calcium ions (mg/dL) released according to the experimental groups at different times
Capital letters mean statistical difference between lines. Lowercase letters mean statistical differences between columns.
STRONGER ANTIMICROBIAL ACTIVITY
BC Temp has been shown to be effective against resistant bacteria such as E faecalis and S aureus at minimal inhibiting concentrations. Under the conditions of the study, a leading competitor did not show antimicrobial activity at the concentration tested.* While more studies are underway to compare BC Temp versus other Ca(OH)2 materials, the manufacturer believes that BC Temp is more effective due to its unique calcium silicate, calcium oxide, and glycol salicylate formulation and the small particle size, which allows for more effective penetration versus conventional Ca(OH)2.
LESS CYTOTOXIC WITH POTENTIAL FOR BETTER HEALING
BC Temp has been shown to be less cytotoxic compared to Ca(OH)2, A recent study concluded that the tissue damage, initially caused by BC Temp (due to the high pH, which is normal and required for a intracanal dressings) is suppressed more quickly compared to those caused by the leading competitor, favoring the repair of connective tissue.*
BETTER COMPATIBILITY BETWEEN BC TEMP AND BIOCERAMIC SEALERS
Push-out tests showed that BC Temp did not influence the reduction of bond strength in teeth filled with bioceramic sealers. Multiple other studies have shown that Ca(OH)2 reduces the bond strength of sealers when there are trace amounts left in the canal.*
IMPROVED HANDLING
BC Temp features a small particle size, so it exhibits optimal flow characteristics. Traditional Ca(OH)2 can be gritty and may be difficult to deliver into the canal. According to our clinical evaluators, BC Temp flows smoothly from the 29-gauge precision tips provided and is easy to apply deep into the canal.
EASIER TO REMOVE
According to a recent study, BC Temp was easier to remove compared to a leading competitor under the conditions of all three of the removal methods. Three different removal methods utilized were a conventional syringe and needle, XP-3D irrigation, and ultrasonic irrigation.*
Microcomputed tomography analysis of percentage (%) of the volume of material removed (mm3) after the use of different intracanal medication removal techniques of BC Temp and a leading competitor
CON = Conventional syringe and needle technique; XP = conventional technique associated with XP Endo Finisher Instrument; US = conventional technique associated with ultrasonic inserts
OBTURATION MATERIALS US : Shop.BrasselerUSA.com or 800.841.4522 | Canada : Shop.Brasseler.ca or 800.363.3838 47
*Data on file.
BC Temp Leading Competitor Removal Technique Used CON XP US CON XP US 86.90 ± 1.11 98.60 ± 1.39 94.70 ± 0.36 82.65 ± 2.43 94.54 ± 1.23 90.32 ± 1.34 % of Material Removal (mm3)
Groups 7 Days 14 Days 21 Days BC Temp 7.32 (0.13)Aa 12.32 (0.15)Ab 15.88 (0.11)Ac Leading Competitor 8.54 (0.21) Aa 7.54 (0.95)Ba 7.85 (0.77)Ba
EndoSequence® BC RRM™



EndoSequence® Root Repair Material (RRM™) is available in two specifically formulated consistencies (syringable paste or condensable putty) and contains many of the same characteristics as BC Sealer. The favorable handling properties, increased strength and shortened set time make RRM highly resistant to washout and ideal for all root repair and pulp capping procedures. Research and countless cases confirm that RRM is highly biocompatible and osteogenic.
SUPERIOR HANDLING
3 Premixed-syringable paste or putty consistency
3 Shortened Set Time (as short as 20 mins)
3 Highly Resistant to Washout
EXCELLENT HEALING
3 Highly Biocompatible
EndoSequence® BC RRM™ Putty:



1 3g Jar
1 Instructions for Use (IFU)
1 Safety Data Sheet (SDS)
Applications: Root Endo Filling (Retrograde fills), Repair of Root Perforation, Repair of Root Resorption, Apexification, Pulp Capping Composition: Calcium silicates, Calcium phosphate monobasic, Calcium hydroxide, Zirconium oxide, Tantalum oxide, Filler and thickening agents

ROOT
48
REPAIR MATERIAL
Order No. 5018264U0 Order No. 5024200U0 Order No. 5026826U0 Order No. 5018266U0
EndoSequence® BC RRM™
The following SEM images illustrate the similarities between MTA and RRM. “Group A” shows the crystalline surfaces of MTA and RRM. Both surfaces are composed primarily of calcium, carbon and oxygen. More notably, “Group B” shows the extent of human gingival fibroblast adhesion to MTA and RRM (after 7 days of incubation). Notice the extensive matrix-like overlay on the surface of the RRM. These SEMs visually confirm that RRM is highly bioactive and efficiently promotes biomineralization.




Group A Group B
Source: Jingzhi M, Shen Y, Stojicic S, Haapasalo M. Biocompatibility of Two Novel Root Repair Materials. JOE. 2011; 37(6): 793-8
EXCELLENT BIOCOMPATIBILITY
3-Day Set Samples
Source: AlAnezi AZ, Jiang J, Safavi KE, Spangberg LSW, Zhu Q. Cytotoxicity evaluation of EndoSequence Root Repair Material. Oral Surgery, Oral Medicine, Oral Pathology, Oral Radiology, and Endodontology. 2010; 109(3): 122-5. DOI:10.1016/j.tripleo.2009.11.028

For a complete bibliography of all of the known published research on these materials please contact Brasseler USA or visit www.BrasselerUSA.com/bioceramics, which is dedicated to sharing information about these revolutionary materials.
‘‘EndoSequence Root Repair Material's favorable properties, coupled with it's ingenious moisture-initiated setting reaction and efficient clinical application, represents a step forward in root repair and surgical retrofilling materials.
Courtesy of Dr. Ali Nasseh, Microsurgical Endodontics, Boston, MA.
AH26™ is a trademark of Dentsply International.

ROOT REPAIR MATERIAL US : Shop.BrasselerUSA.com or 800.841.4522 | Canada : Shop.Brasseler.ca or 800.363.3838 49
MTA Crystaline Surface RRM Crystaline Surface
MTA Fibroblast Adhesion RRM Fibroblast Adhesion
A = EndoSequence® Root Repair Material B = Gray MTA C = White MTA D = AH26 Cell Viability 120% 100% 80% 60% 40% 0% 20% Elute Medium (600µL) Elute Medium (300µL) A B C D A B C D A B C D Elute Medium (1mL)
’’
BIOACTIVE
- Dr. Ali Nasseh Microsurgical Endodontics Boston, MA
EndoSequence® BC Liner™

EndoSequence BC Liner is Brasseler’s latest innovation in the line of revolutionary EndoSequence BioCeramic Materials. Unlike BC Sealer™ and BC RRM™ (Root Repair Material), BC Liner is dual-cure and is designed to bridge the gap between pure calcium silicate based bioceramics and more user-friendly, light-curable bioactive restorative materials. EndoSequence BC Liner is a next-generation bioactive hybrid resin optimized for use with BC Sealer and BC RRM. This versatile and durable material chemically bonds to dentin without the need for a bonding agent. The unique, moisture-friendly chemistry seals teeth against bacterial leakage and continuously releases and recharges calcium, phosphate and fluoride ions for a lasting biological benefit.

CORE BUILD-UP MATERIAL
BPA FREE! Available in Blue for Orriface Barriers!
Clinical photograph courtesy of Allen Ali Nasseh, DDS, MMSc
EndoSequence® BC Liner™
LASTING PROTECTION AGAINST CORONAL LEAKAGE
Currently most endodontists utilize cotton and Cavit™ to cover their obturated canals. It is widely known that these materials provide virtually no protection from the bacteria-laden oral cavity. It is our mission to advance the standard of care by introducing this user-friendly, cost-effective solution for sealing the orifices of obturated root canals. Furthermore, EndoSequence BC Liner also provides an important function by protecting BC RRM (and ultimately the final restoration) after a repair or pulp capping procedure is performed. Up to this point, clinicians have had to use weaker, less biocompatible and less bioactive materials for this function. Unlike other RMGICs, EndoSequence BC Liner does not contain Bisphenol A, Bis-GMA or BPA derivatives.
BC Liner is provided with 40 BC Liner Short Tips. As with all automix materials it is advised to bleed out a small amount of material from each side of the syringe prior to placing the mixing tip. BC Liner is priced very reasonably to account for this small amount of waste.

EndoSequence® BC Liner™:
1 BC Liner
40 BC Liner Short Tips
1 Safety Data Sheet (SDS)
Order No. 5027169U0
EndoSequence® BC Liner™ Blue:

1 BC Liner Blue
40 BC Liner Short Tips
1 Safety Data Sheet (SDS)
Order No. 5027706U0
BC Liner Short Tips are ideal for covering root canal orifices with a thin layer material. These tips are provided with each box of BC Liner and are sold separately. The shorter mixing tip and narrow cannula minimize waste.

BC Liner’s automix syringe features an exclusive, ergonomic finger grip, which provides more leverage for smooth, easy and precise dispensing.

Order No. 5027158U0
BC Liner Long Tips provide for a more homogeneous mixture and are ideal for larger backfills. The wider cannula allows for easy dispensing. These tips are only sold separately.
Order No. 5027159U0
BASE/LINER & CORE BUILD-UP MATERIAL US : Shop.BrasselerUSA.com or 800.841.4522 | Canada : Shop.Brasseler.ca or 800.363.3838 51
Cavit™ is a trademark of 3M.
BC Liner™ Short Tips (40/Pack)
BC Liner™ Long Tips (20/Pack)
EndoSequence® Core Build-Up Material + (CBM+™)
EndoSequence Core Build-Up Material + is a multi-purpose build-up and post cementation material that features an ideal balanced viscosity. This highly radiopaque, fluoride-releasing, dual-cure material has outstanding strength and is syringeable, while also being stackable. Unlike other core materials, there is virtually no perceivable difference between cutting EndoSequence CBM+ and natural dentin. The unique moisturetolerant chemistry has self-adhesive and self-etching properties, which make bonding agents optional when there is a retentive form preparation. Unlike other core build-up materials, EndoSequence CBM+ does not contain Bisphenol A, Bis-GMA or BPA derivatives.
Clinical Indications
· Vital tooth build-up for crown prep
· Core build-up after endo
· Post cementation
· Direct bonded core (intraradicular core build-up without a post)
· Base/liner under restorations
EndoSequence Core Build-Up Material +:
1 ES CBM+ Cartridge
30 ES CBM+ Automix Tips 30 ES CBM+ Delivery Tips
1 Safety Data Sheet (SDS)
Physical Properties
Compressive strength: 44,080 psi / 304 MPa
Flexural strength: 14,065 psi / 97 MPa



Setting/curing time at 37°C (99°F): 3:15 minutes
Light-cure setting time: 20 seconds
Depth of cure: 4mm
BASE/LINER & CORE BUILD-UP MATERIAL 52
Order No. 5027162U0
Order No. 5027170U0
Order No. 5027164U0
Order No. 5027161U0
BPA FREE!
CBM+™ Automix Tips (30/Pack)
CBM+™ Delivery Tips (30/Pack)
CBM+™ Dispensing Gun
EndoSequence® Post System
EndoSequence can be likened to a prefabricated cast post because the shape/preparation created by your EndoSequence file also serves as your post space. There is no need to alter the shape of the canal with a post drill which can cause unwanted stress on the tooth.
EndoSquence posts are white and translucent, making them ideal for highly esthetic restorations. Each post is factory silanated to facilitate optimal bonding and they are highly radiopaque.

EndoSequence posts are extremely strong and have a modulus of elasticity similar to that of dentin which results in less stress on the tooth.
Features:
• High Zirconia content (68%) gives increased strength
• Low modules of elasticity (49GPf) promotes natural movement of surrounding tooth structure
• Factory silanation ensures proper chemical and micro-mechanical bonding for dual and light cure resins
• High radiopacity for clear post-op radiographs
• White composite fiber composition ideal for highly esthetic restorations

Technique:
• Simply burnout the neccessary amount of gutta percha or pre-cut the cone to create the desired apical plug.
EndoSequence Post General Selection Guidelines
EndoSequence File/ Post
POST SYSTEMS US : Shop.BrasselerUSA.com or 800.841.4522 | Canada : Shop.Brasseler.ca or 800.363.3838 53
Elasticity Modulus GPa 250 200 150 100 50 0% 200 120 141 49 25 Steel Titanium Carbon EndoSequence Dentin EndoSequence Posts (5/Pack) Tip ID Tip Size .04 Taper .06 Taper Yellow .50 5013508U0 5013512U0 Red .70 5013509U0 5013513U0 Blue .90 5013510U0 5013514U0 Green 1.0 - 5013515U0 Green 1.1 5013511U0K0165 EndoSequence® Post Starter Kit (.04 Taper): 5 ea. (sizes .50-1.1) EndoSequence Posts (.04 Taper) 1 Universal Finishing Diamond 1 Hand Driver 1 Instructions for Use (IFU)
5 ea. (sizes
EndoSequence
1 Universal Finishing Diamond 1 Hand Driver 1 Instructions for Use (IFU) Order No. 5015623U0 Order No. 5015624U0
K0166 EndoSequence® Post Starter Kit (.06 Taper):
.50-1.0)
Posts (.06 Taper)
Drill
EndoSequence
be Used
Tip Size 30 Tip Size .50 Tip Size 50 Tip Size .70 Tip Size 70 (.04 Taper Only) Tip Size .90 Tip Size 80 (.04 Taper Only) Tip Size 1.1
EndoSequence File/ Post
(.04 Taper)
Post to
(.04 Taper)
Drill
be
Tip Size 30 Tip Size .50 Tip Size 50 Tip Size .70 Tip Size 50 (Work Circumpherically to Expand) Tip Size .90 Tip Size 50 (Work Circumpherically to Expand) Tip Size 1.0
(.06 Taper) EndoSequence Post to
Used (.06 Taper)
DentFlex™ Post System
DentFlex Posts are composed of the same material as EndoSequence Posts, but utilize a post drill and are parallel except for the tip.
• High Zirconia content (68%) gives increased strength
• Low modules of elasticity (49GPf) promotes natural movement of surrounding tooth structure
• Factory silanation ensures proper chemical and micro-mechanical bonding for dual and light cure resins
• High radiopacity for clear post-op radiographs
• White composite fiber composition ideal for highly esthetic restorations

• Matching drills to facilitate ideal placement
DentFlex Posts (10/Pack)

Tip ID Tip Size 3° Taper
White 1.0 5013913U0
Yellow 1.2 5013914U0
Red 1.4 5013915U0
Blue 1.6 5013916U0
DentFlex Drills (1/Pack)
Tip ID Tip Size 3° Taper
White 1.0 5013917U0
Yellow 1.2 5013918U0
Red 1.4 5013919U0
Blue 1.6 5013920U0
DentFlex Kits

POST SYSTEMS 54
DentFlex Refill Kit: 10 1.0 mm DentFlex Posts 1 1.0 mm DentFlex Drill
DentFlex Introductory Kit: 5 1.0 mm DentFlex Posts 5 1.2 mm DentFlex Posts 5 1.4 mm DentFlex Posts 5 1.6 mm DentFlex Posts 1 1.0 mm DentFlex Drill 1 1.2 mm DentFlex Drill 1 1.4 mm DentFlex Drill 1 1.6 mm DentFlex Drill DF120 DentFlex Refill Kit: 10 1.2 mm DentFlex Posts 1 1.2 mm DentFlex Drill DF140 DentFlex Refill Kit: 10 1.4 mm DentFlex Posts 1 1.4 mm DentFlex Drill DF160 DentFlex Refill Kit: 10 1.6 mm DentFlex Posts 1 1.6 mm DentFlex Drill Order No. 5013909U0 Order No. 5013908U0 Order No. 5013910U0 Order No. 5013911U0 Order No. 5013912U0 Elasticity Modulus GPa 250 200 150 100 50 0% 200 120 141 49 25 Steel Titanium Carbon DentFlex Dentin
DF110
DF100
Vlock™ & Vario™ Titanium Post Systems
• Color coded identification system matches the correct drill, root facer and wrench to each post • Unique drill design creates the optimal parallel post preparation without the need for gates or peeso reamers
• Vlock posts feature a unique tapered head design which provides optimal surface area for mechanical retention of core material
• Vlock and Vario Active Posts feature a threaded design for maximum retention
• Vlock Passive Posts feature retention grooves and are recommended for brittle teeth





• Posts are manufactured of high quality pure titanium

• Post accessories are manufactured of high quality stainless steel and are highly resistant to corrosion from sterilization
Vlock Post System
For cases when sufficient space for a post head is available.
Vario Post System
For cases when insufficient space for a post head is available.
POST SYSTEMS US : Shop.BrasselerUSA.com or 800.841.4522 | Canada : Shop.Brasseler.ca or 800.363.3838 55
Vlock™ Active Posts Vlock™ Passive Posts Length Standard Long Standard Long Size 1 2 3 1 2 3 1 2 3 1 2 3 Color Order Number T63L6.1 T63L7.2 T63L9.3 T51L13.1 T52L13.2 T53L13.3 T64L6.1 T64L7.2 T64L9.3 T54L13.1 T55L13.2 T56L13.3 Shank Dia. D (mm) 1.30 1.50 1.75 1.30 1.50 1.75 1.15 1.35 1.60 1.15 1.35 1.60 Shank Dia. L (mm) 6.0 7.0 9.0 13.0 13.0 13.0 6.0 7.0 9.0 13.0 13.0 13.0 Head Dia. D (mm) 2.5 3.0 4.0 2.5 3.0 4.0 2.5 3.0 4.0 2.5 3.0 4.0 Head Length L (mm) 2.75 3.85 4.90 2.75 3.85 4.90 2.75 3.85 4.90 2.75 3.85 4.90 Root Facers 116.21.1 116.21.2 116.21.3 116.21.1 116.21.2 116.21.3 116.21.1 116.21.2 116.21.3 116.21.1 116.21.2 116.21.3 Drills 1791.21.012 1792.21.014 1793.21.016 179L1.21.012 179L2.21.014 179L3.21.016 1791.21.012 1792.21.014 1793.21.016 179L1.21.012 179L2.21.014 179L3.21.016 Wrenches 66L6 66L7 66L9 66L6 66L7 66L9 66L6 66L7 66L9 66L6 66L7 66L9 Kits* 4118 4119 4120 4123 4124 4125 4128 4129 4130 4133 4134 4135 Combo Kits** 4122 4127 4132 4137 Vario™ Active Posts Length Standard Long Size 1 2 3 1 2 3 Color Order Number T91L6.1 T92L7.2 T93L9.3 T91L13.1 T92L13.2 T93L13.3 Shank Dia. D (mm) 1.30 1.50 1.75 1.30 1.50 1.75 Shank Dia. L (mm) 6.0 7.0 9.0 13.0 13.0 13.0 Head Dia. D (mm) 1.30 1.50 1.75 1.30 1.50 1.75 Head Length L (mm) 3.50 3.50 3.50 3.50 3.50 3.50 Drills 1791.21.012 1792.21.014 1793.21.016 179L1.21.012 179L2.21.014 179L3.21.016 Wrenches 127.1 127.2 127.3 127.1 127.2 127.3 Kits* - - - 4191 4192 4193 Combo Kits** - 4190
*Includes 10 posts, 1 drill, 1 wrench **Includes 15 posts (5 of each), 3 drills (1 of each), 3 wrenches (1 of each)
EndoSync™ Plus
The dynamic design of the EndoSync Plus Cordless offers the market’s only torque controlled, open-platform software that allows for complete customization of motion; an unprecedented feature in the industry. This high performance endodontic micromotor is the lightest cordless handpiece in its class with numerous safety features, including: Optimized Torque Reverse (OTR) technology, torque slowdown, and highly intuitive apical actions when connected to the EndoSync A.I. Apex locator. The EndoSync Cordless offers the safety you deserve with the efficiency you require.

EndoSync Plus
Set Includes Motor, Head, Charging Base
Weight: 100 grams
6 Memory Settings
Programmable Motions
Speed Range: 50-1,000 rpm
Rechargeable Lithium Ion Batteries
1-Year Warranty
Order No. 5027135U0
Designed to be used with Brasseler ESR CM files and all rotary and reciprocating NiTi systems

POWER SYSTEMS 56
EndoSync™ A.I.
The EndoSync A.I. Apex Locator features the latest innovative design and technology in endodontic measurements, all encompassed in a lightweight, compact system. Equipped with automatic calibration, a memory bar, audible warnings, and a large LCD screen, the EndoSync A.I. delivers precision to meet your endodontic needs.


EndoSync A.I.
Weight: 110 grams
Size (mm): 60 (w) × 103 (d) × 57 (h)
Battery: DC 1.5V AAA
3 Memory Settings
1-Year Warranty
Order No. 5025412U0
EndoSync Transmission Cable
Required to connect EndoSync Cordless to EndoSync A.I.
Order No. 5025552U0
SIMPLE
The lightweight, compact and portable design features an easy-to-operate panel with three memory settings.
SAFE
With the latest technology in endodontic measurements, the EndoSync A.I. accurately determines the file’s location in a variety of canal conditions. The accuracy is unaffected by the presence of blood, electrolytes, saline or irrigants in the canal.
SMART
Automatically calibrates to meet canal conditions during treatment including changes to temperature and moisture with the ability to work in synchronization with the EndoSync Cordless.
POWER SYSTEMS US : Shop.BrasselerUSA.com or 800.841.4522 | Canada : Shop.Brasseler.ca or 800.363.3838 57
EndoSequence® 2
SAFE. PREDICTABLE. PRECISE.
The portable EndoSequence 2 and EndoDrive Plus endodontic micromotors from Brassler USA are versatile platforms for successful root canal treatment. The lightweight EndoDrive Plus offers an easy-to-read LCD screen while the EndoSequence 2 provides the flexibility of a cordless device. Both systems feature a miniature head for excellent visibility during procedures and the safety and comfort that comes with torque control and auto reverse.


EndoSequence® 2 Complete Set
Set Includes Motor, Head, Charging Base
5 Programmable Settings
Auto Reverse
Torque Control
Speed Range: 200-1,000 rpm
AAA Rechargable Batteries
1-Year Warranty
Order No. 5021327U0
EndoDrive Plus™
EndoDrive Plus Complete Set
Set Includes Motor, Head, Control Unit and AC Adapter
9 Programmable Settings
Auto Reverse
Torque Control
Speed Range: 100-650 rpm
1-Year Warranty
Order No. 5021328U0
POWER SYSTEMS 58
EndoPro 270™

A NEW GENERATION OF ENDODONTIC TECHNOLOGY






The EndoPro 270 powered heat source from Brasseler USA ushers in a new generation of technology for successful root canal treatments. The EndoPro 270 is the most advanced power heat source on the market with a remarkable ergonomic design.The advanced powered heat source of the EndoPro 270 delivers the superior benefits required in your practice.

TOP 50
EndoPro 270 Complete Set
Set Includes Handpiece, Charging Base, and Heated Plugger
4 Hours of Continual Use With Single Charge
Weight: 63 g
6 Temperature Settings up to 270°C
1-Year Warranty
Order No. 5019927U0
EndoPro 270 Pluggers

Description SML (45/04) MED (55/08) LRG (60/12) SML/MED (55/06)
Order No. 5019928U0 5019929U0 5019930U0 5019931U0
Description MED/LRG (55/10) Thin Spreader Vitality Testing Tip


Order No. 5019932U0 5019933U0 5019934U0

US : Shop.BrasselerUSA.com or 800.841.4522 | Canada : Shop.Brasseler.ca or 800.363.3838 59
2011
Technology Products
Forza™ V3
ELEGANT AND INTUITIVE
The slim, ergonomic design of the Forza V3 handpiece provides excellent access while the LED illumination from dual fiber optics delivers clearer vision and maximum visibility. With a wide range of piezo ultrasonic tips available, the Forza V3 is ideal for a variety of clinical procedures including general scaling, perio and endo.



Forza V3 LED Complete Set
Set includes Control Unit, Handpiece, Control Unit Holder, Water Filter and Connector Set, Foot Control, Tip Wrench, AC Adapter, Three Scaling Tips (G1, G9, G11)
LED Fiber Optic

General, Perio & Endo Modes
Easy Power & Water Adjustment
Piezo Accelerator Mode
Order No. 5023152U0
Forza V3 Non-Optic Complete Set
Set includes Control Unit, Handpiece, Control Unit Holder, Water Filter and Connector Set, Foot Control, Tip Wrench, AC Adapter, Three Scaling Tips (G1, G9, G11)
Non-Fiber Optic
General, Perio & Endo Modes
Easy Power & Water Adjustment
Piezo Accelerator Mode
Order No. 5023153U0
ULTRASONICS 60
Ultrasonic Tips
E4 5011379U0
E4D 5025641U0
E5 5010233U0
E6 5010234U0
E7 5010235U0
E7D 5025642U0
E8 5010236U0
E8D 5025643U0
E9 5012561U0
E9D 5025644U0
E14D 5025645U0
Water cooled For root canal cleaning
Water cooled Diamond coated Non-coated tip For root canal cleaning










































Lateral condensation
E15 5019426U0
E15D 5026546U0
E16D 5019427U0
Lateral condensation
E17D 5019428U0
Removal of filling and foreign material
Water cooled Diamond coated Enlargement of root canal wall
Removal of filling and foreign material
Water cooled Diamond coated Enlargement of root canal wall
Water cooled Removal of filling and foreign material
Water cooled Diamond coated Troughing Access refinement
Water cooled Diamond coated Enlargement of root canal wall
Water cooled Post removal
Water cooled Diamond coated Pulp stone removal Troughing
Water cooled Diamond coated Troughing Access refinement
Ditching and posts Paste removal Chasing calcified canals Instrument removal
ULTRASONICS US : Shop.BrasselerUSA.com or 800.841.4522 | Canada : Shop.Brasseler.ca or 800.363.3838 61
Endo
Ultrasonic Tips
Endo
E18D 5019429U0
E19D 5019430U0
Ditching and posts
Paste removal
Chasing calcified canals
Instrument removal
Ditching and posts
Paste removal
Chasing calcified canals
Instrument removal E20 5019431U0
Titanium alloy Instrument removal

Titanium alloy
Instrument removal E22 5019433U0
Titanium alloy Instrument removal V30
For root canal cleaning (17 mm)
Pack of 3
For root canal cleaning (23 mm)













Pack of 3
For root canal cleaning (26 mm)


Pack of 3 VS53 5013306U0
VS50D 5025651U0
VS51D 5025652U0
For root canal cleaning (32 mm)
Pack of 3
Diamond coated For root canal enlargement (17 mm)

Pack of 3
Diamond coated For root canal enlargement (23 mm)
Pack of 3 VS52D 5025653U0
VS53D 5025654U0
Each pack of V30 includes one (1) E Tip replacement wrench. Replacement wrench is not included when ordering other tips. Please order the replacement wrench separately in this instance.
Diamond coated For root canal enlargement (26 mm)
Pack of 3
Diamond coated
For root canal enlargement (32 mm)
Pack of 3
ULTRASONICS 62
E21 5019432U0
5010251U0
V-Tip Holder
VS50 5013303U0
VS51 5013304U0
VS52 5013305U0
Endodontic V-Tip
Ultrasonic Tips


















Retrograde Endo - Standard Length (BEST - Brasseler Endo Surgery Tips)

BEST 1D 5019434U0
BEST 2D 5019435U0
BEST 3D 5019436U0
BEST 4D 5019437U0
BEST 5D 5019438U0
BEST 6D 5019439U0
Retrograde Endo - Shorter Length
E30RD 5025647U0
E30LD 5025648U0
E31D 5025649U0
E32D 5025650U0
Diamond coated For anterior teeth (see chart)
Diamond coated For anterior teeth (see chart)
Diamond coated For posterior teeth (see chart)
Diamond coated For posterior teeth (see chart)
Diamond coated For posterior teeth (see chart)
Diamond coated For posterior teeth (see chart)
Working Zones
Diamond coated For posterior teeth (right angled)
Diamond coated For posterior teeth (left angled)
Diamond coated For anterior and posterior teeth (70°)





Diamond coated For anterior teeth (90°)






ULTRASONICS US : Shop.BrasselerUSA.com or 800.841.4522 | Canada : Shop.Brasseler.ca or 800.363.3838 63 Tip No. Teeth No. BEST 1D & 2D 6-11 & 22-27
3D 2-5 & 16-21 BEST 4D 2-5 & 18-19 BEST 5D 12-15 & 28-31 BEST 6D 12-15 & 30-31
BEST
8 9 10 11 12 13 14 15 7 6 5 4 3 2 31 30 29 28 27 26 25 24 23 22 21 20 19 18
Ultrasonic Tips
U Files
E11 5010249U0
E12 5010250U0
Each pack of E11 or E12 includes one (1) E Tip replacement wrench. Replacement wrench is not included when ordering other tips. Please order the replacement wrench separately in this instance.
Application Tip Code
Access Refinement E9D, E14D, E16D
Troughing for Orifices E9D, E14D, E15D, E16D

Pulp Stone Removal E15D, E16D, E17D
Post Removal E4, E9, E15
Obturation Material Removal E17D-E22
Ultrasonic Tip Kit
Order No. 5019698U0
Application
Tip Code
Broken Instrument Removal E20-E22
Core/Restorative Material Removal E9D, E15, E15D, E16D, E17D
Chasing Calcified Canals E17D-E19D
Canal Shaping
Acoustic Streaming
E11/E12 with U Files
All Non-Diamond Coated Tips & U Files
K0209 Ultrasonic Tip Kit:







1 E4 Tip
1 E9 Tip
1 E9D Tip
1 E14D Tip
1 E15D Tip
1 A641 Black Aluminum Tip Caddy




Order No. 5025741U0
Order No. 5019700U0
Order No. 5019770U0
Power Settings: For all ultrasonic tips the practitioner should start at the lowest power setting on their unit and incrementally increase the power if needed. Long and narrow tips should always be used at the lowest functional power setting.
Water Spray: All Brasseler Endo Ultrasonic tips contain water ports which are designed to keep the tip cool during use. Most specialists do not condone the use of nonwater cooled tips for endodontic applications.




ULTRASONICS 64 95 120˚
For
For anterior teeth
For U files (shank dia: 0.8 mm)
root canal cleaning
For
For
Pack of 6 ISO15
Pack of 6 ISO20
5010200U0 Pack of 6 ISO25
5010201U0 Pack of 6 ISO30
Pack of 6 ISO35
For U files (shank dia: 0.8 mm)
root canal cleaning
posterior teeth U Files #15 5010198U0
U Files #20 5010199U0
U Files #25
U Files #30
U Files #35 5010202U0
A641 Ultrasonic Tip Caddy
CR-10 Torque Limiting Wrench CR-2 Standard Tip Wrench
Hand Instruments
Crown Removers & Spreaders
• Used to remove permanent and temporary crowns.
Kline Crown Remover for bicuspids and molar crowns


Crown Spreader
Three surfaces set at different angles for easy adaptation for crown removal
Crown Spreader • Elite Handle

Three surfaces set at different angles for easy adaptation for crown removal
Crown Spreader • Also known as ZENA
• Endo Pliers have horizontal and vertical grooves to align and hold fine gutta percha points during endodontic procedures.

Locking Endo Plier
Non-Locking Endo Plier
HAND INSTRUMENTS US : Shop.BrasselerUSA.com or 800.841.4522 | Canada : Shop.Brasseler.ca or 800.363.3838 65
Endo
Pliers CRZ 300 300NL EB134 B134 240097K00 Order No. 5001266U0 Order No. 5023313U0 Order No. 5001865U0 Order No. 5008928U0 Order No. 5023316U0 #4 Handle 5023314U0 #6 Handle 5023315U0
Grooved
Hand Instruments
Explorers - Double End
• Endodontic explorers are designed with longer working ends and are used to locate canal orifices.




Excavators
• Endodontic excavators have long shank spoons for dentin removal from the base of the pulp chamber.
HAND INSTRUMENTS 66 #2 Handle 5023540U0 #4 Handle 5023546U0 #6 Handle 5023549U0 #2 Handle 5023534U0 #4 Handle 5023535U0 #6 Handle 5023536U0 #2 Handle 5023537U0 #4 Handle 5023538U0 #6 Handle 5023539U0 #2 Handle 5023541U0 #4 Handle 5023547U0 #6 Handle 5023548U0 #2 Handle 5023542U0 #6 Handle 5023543U0 #2 Handle 5023544U0 #6 Handle 5023545U0 #2 Handle 5023531U0 #6 Handle 5023532U0 #6 Handle 5023533U0
70° 45° 70° 70° 70° 70°
Long extended shank Long extended shank Long extended shank Long extended shank 1.2 mm 1.5 mm 1.5 mm 2.0 mm EXEDG16 EXEDG16/16
EXCE31L EXCE31W EXCE32L EXCE33L
EXEDG16/17 EXEDG16/23
Hand Instruments
Pluggers - Single End
• Endodontic Pluggers are used to condense filling material vertically. • Pluggers have marking at 5mm intervals.
Pluggers - Double End
• Endodontic Pluggers are used to condense filling material vertically.





• Pluggers have marking at 5mm intervals.

HAND INSTRUMENTS US : Shop.BrasselerUSA.com or 800.841.4522 | Canada : Shop.Brasseler.ca or 800.363.3838 67
#2 Handle 5023552U0 #4 Handle 5023553U0 #6 Handle 5023554U0
.5 mm 1.0 mm .75 mm 1.15 mm 1.1 mm
.4 mm .55 mm .75 mm PLE8 PLG14 PLE9 PLE5/7 PLE10 PLE9/11 #6
#4
5023551U0
Handle 5026158U0 #6 Handle 5026159U0 #6 Handle 5026160U0
Handle 5023550U0 #4 Handle
21mm Long Tips .02 Taper GLICK-1 Blade/Plugger 21mm Long Tips .02 Taper
Hand Instruments
Stainless Steel Spreaders • Single End
• Endodontic spreaders are used to compact filling material laterally.
23 mm .04 Taper Standard
21 mm .04 Taper Thin
SED11TS
21 mm .04 Taper Thinnest
Nickel Titanium Spreaders • Single End
• Endodontic spreaders are used to compact filling material laterally.
• NaviFlexNT® nickel titanium hand spreaders provide greater flexibility and extra strength.








SED11TSNT
21 mm .04 Taper Thinnest
NTD11T
SED11T SE25NT
D11T-Endo • 21 mm Thinner
D11T-Endo • 25 mm Thinner
SEMA57NT
MA5728 • Spreader • 28 mm
NT4SP
Spreader 21 mm
HAND
68
INSTRUMENTS
#2 Handle 5023558U0 #6 Handle 5023560U0 #2 Handle
#4 Handle 5009518U0 #6 Handle 5009752U0 #6 Handle
#2 Handle
#4 Handle
#2 Handle 5023561U0 #6 Handle 5023563U0 #6 Handle
5007773U0
5026165U0
5007776U0
5009521U0
5026166U0 SED11
#6 Handle 5026163U0 #6 Handle 5026164U0
Hand Instruments Stieglitz




Order No. 5023705U0
Order No. 5023706U0
Order No. 5024824U0
Order No. 5024825U0
HAND INSTRUMENTS US : Shop.BrasselerUSA.com or 800.841.4522 | Canada : Shop.Brasseler.ca or 800.363.3838 69
ST45 ST90
Bent at 45° • Stainless steel micro forceps for removing obstructions or debris from the root canal Serrated tips - 5 ¼ in
Bent at 90° • Stainless steel micro forceps for removing obstructions or debris from the root canal Serrated tips - 4 ¾ in
Micro Steiglitz Forceps 45°
Micro Steiglitz Forceps 90°
Castroviejo
Endo Black™ Premium Instruments
Endo Black instruments are lightweight, ideally balanced and feature a unique knurled handle for precision dexterity. The tips feature an exclusive, anti–reflective DLC (diamond-like carbon) coating, which improves cutting edge fidelity and inhibits reflective light, which is a common issue under high magnification.


Dressing Forceps


Mirror Handles and Mirrors
Mirror Handle - Double End Simple Stem/European Style
Order No. 5026961U0
Order No. 5026962U0
Mirror Handle - Single End Simple Stem/European Style
Order No. 5026969U0
Mirror Face (12/Pack)

Simple Stem/European Style #4 7/8 Inch Diameter
Order No. 5026970U0
Order No. 5026963U0
Order

SURGICAL
70
HAND INSTRUMENTS
Round Micro Mirror (.5 mm)
Oval Micro Mirror (3 x 6 mm)
No. 5026964U0
Endo Black™ Premium Instruments


Endo Black Surgical System



SURGICAL HAND INSTRUMENTS US : Shop.BrasselerUSA.com or 800.841.4522 | Canada : Shop.Brasseler.ca or 800.363.3838 71 Explorer DG16 Order No. 5026968U0 SG13/14 Mini Gracey Curette Order No. 5026952U0 Micro Blade Mirror Holder 7 mm Order No. 5028592U0 Micro Mirror 2 mm SS Flex Order No. 5028589U0 Micro Mirror 3 mm SS Flex Order No. 5028590U0 Micro Mirror 4 mm SS Flex Order No. 5028591U0
Endo Black™ Premium Instruments

SURGICAL
72
HAND INSTRUMENTS
Prichard Periosteal Elevator
Order No. 5026966U0
Ball Burnisher/Carver #2
Order No. 5026960U0
PPR2/4 Periosteal Elevator, Sharp Order No. 5026956U0
GTEXC1 Granulation Tissue Excavator Order No. 5026954U0
SC13/14 Posterior Columbia Curette Order No. 5026953U0
GTEXC2 Granulation Tissue Excavator Order No. 5026955U0
Endo Black™ Premium Instruments




SURGICAL HAND INSTRUMENTS US : Shop.BrasselerUSA.com or 800.841.4522 | Canada : Shop.Brasseler.ca or 800.363.3838 73
PM9 Periosteal Elevator
Order No. 5026957U0
Micro Plugger .50 mm LR
Order No. 5026958U0
Micro Plugger .75 mm LR
Order No. 5026959U0
PLEMICRO1 Micro Plugger .6 mm LR
Order No. 5028588U0
PLEPR Perforation Repair Plugger
Order No. 5028587U0
Endo Black™ Premium Instruments

GPR (Gutta Percha Removal)




SURGICAL
INSTRUMENTS 74
HAND
30 mm
EGPR LR
Order No. 5026971U0 EGPR UD 30 mm
Order No. 5026975U0 EGPR LR 18 mm Order No. 5026976U0
EGPR UD 18mm
Order No. 5026977U0
ELES LR DC 18/30 mm Diamond Coated
Order No. 5027004U0
Endo Black™ Premium Instruments
SINSTC Surgical Cassette with Lid Adjustable to 3 Different Depths Dimensions: 10 ¾ in x 7 in Adjustable to 3 depths: 1 in



SURGICAL HAND INSTRUMENTS US : Shop.BrasselerUSA.com or 800.841.4522 | Canada : Shop.Brasseler.ca or 800.363.3838 75
MTA Delivery/Carver Order No. 5027030U0
1
1
¼ in
1/2 in Order No. 5026967U0 MTA Block Order No. 5026965U0
XP-3D™ Kits
K0336 XP-3D™ Intro Kit:

2 XP-3D Shaper RF30 25mm (3/pk)
1 XP-3D Shaper RF30 21mm (3/pk)
1 XP-3D Finisher R RF30 25mm (3/pk)
1 BC Points/Paper Points Asst Wheel .04 15-60
1 EndoSequence BC Sealer
1 XP-3D Chairside Guide
Order No. 5026130U0
K0338 XP-3D™ Starter Kit:

6 XP-3D Shaper RF30 25mm (3/pk)
10 XP-3D Shaper RF30 21mm (3/pk)
4 XP-3D Shaper RF30 31mm (3/pk)
4 XP-3D Finisher R RF30 25mm (3/pk)
4 XP-3D Finisher R RF30 21mm (3/pk)
2 ESX Scouting File 15 .04 21mm (3/pk)
2 ESX Scouting File 15 .04 25mm (3/pk)
1 ESX Scouting File 15 .02 25mm (3/pk)
1 ESX Orifice Shaper 20 .08 19mm (3/pk)
5 KontrolFlex Stiff K-File 08 25mm (6/pk)
5 KontrolFlex Stiff K-File 10 25 (6/pk)
5 KontrolFlex Stiff K-File 15 25 (6/pk)
1 BC Points/Paper Points Asst Wheel .04 15-60
1 EndoSequence Canal Clean (100mL)
1 EndoSequence Lubricant
1 EndoSequence BC Sealer
1 XP-3D Chairside Guide
Order No. 5026135U0
PROCEDURE SYSTEMS 76
ESR™ CM Kits


K0402 ESR™ CM Intro Kit:
3 ESR CM #20 25 mm (3/pk)
3 ESR CM #25 25 mm (3/pk)
3 ESR CM #30 25 mm (3/pk)
2 ESR CM #40 25 mm (3/pk)
2 ESR CM #50 25 mm (3/pk)
1 ESR CM Scout C #15 25 mm (3/pk)
1 BC GP .04 #20 (60/pk)
1 BC GP .06 #25 (60/pk)
1 BC GP .04 #30 (60/pk)
1 BC GP .04 #40 (60/pk)
1 BC GP .04 #50 (60/pk)
1 EndoSequence BC Sealer
Order No. 5028422U0
K0404 ESR™ CM Starter Kit:
1 BC GP .04 #30 (60/pk)
1 BC GP .04 #40 (60/pk)
1 BC GP .04 #50 (60/pk)
1 EndoSequence BC Sealer
Order No. 5028423U0
US : Shop.BrasselerUSA.com or 800.841.4522 | Canada : Shop.Brasseler.ca or 800.363.3838 77
PROCEDURE SYSTEMS
9
9 ESR
9 ESR
ESR CM
ESR CM
ESR CM #20 25 mm (3/pk)
CM #25 25 mm (3/pk
CM #30 25 mm (3/pk) 6
#40 25 mm (3/pk) 6
#50 25 mm (3/pk) 5 ESR CM #20 21 mm (3/pk) 5 ESR CM #25 21 mm (3/pk) 5 ESR CM #30 21 mm (3/pk) 5 ESR CM Scou C #15 25 mm (3/pk) 5 ESR CM Scout C #15 21 mm (3/pk) 1 BC GP .04 #20 (60/pk)
1 BC GP .06 #25 (60/pk)
EndoSequence® Blend Kits
K0397 EndoSequence® Blend Intro Kit:


3 ES-CM #30 .04 25 mm (4/pk)
1 ES-CM #35 .04 25 mm (4/pk)
1 ES-CM #40 .04 25 mm (4/pk)
1 ES Scout #25 .04 25 mm (4/pk)
1 ES Scout #20 .04 25 mm (4/pk)
1 BC Obturation Kit .04 (BC Sealer + GP Wheel)
Order No. 5027689U0
K0398 EndoSequence® Blend Starter Kit:
8 ES-CM #30 .04 25 mm (4/pk)
5 ES-CM #35 .04 25 mm (4/pk)
4 ES-CM #40 .04 25 mm (4/pk)
5 ES Scout #25 .04 25 mm (4/pk)
5 ES Scout #20 .04 25 mm (4/pk)
2 ES #20 .08 16mm (4/pk)
5 KontrolFlex Stiff K-File 08 25 mm (6/pk)
5 KontrolFlex Stiff K-File 10 25 mm (6/pk)
5 KontrolFlex Stiff K-File 15 25 mm (6/pk)
1 BC GP Assortment .04 #15-#60 (300p)
1 EndoSequence Lubricant (3x3g syringe)
1 EndoSequence BC Sealer
1 Canal Clean 100mL
Order No. 5027690U0
PROCEDURE SYSTEMS 78
EndoSequence® Kits
EndoSequence® Access Kit

EndoSequence® Rotary Files Kit
EndoSequence® .04 Trial Pack:
1 K000032 EndoSequence Access Kit
3 Expeditor 21 .04 16mm (4/pk)
2 Small/Extra-Small File Asst 15-30 .04 25mm (4/pk)

2 Medium File Asst 25-40 .04 25mm (4/pk)
2 Large File Asst 35-50 .04 25mm (4/pk)
1 Gutta Percha/Paper Points Asst Wheel .04 15-60
2 EndoSequence K-File Asst 8-20 .02 25mm (6/pk)
1 EndoSequence Chairside Guide
EndoSequence® .06 Trial Pack:
1 K000032 EndoSequence Access Kit
3 Expeditor 21 .06 16mm (4/pk)
2 Small/Extra-Small File Asst 15-30 .06 25mm (4/pk)

2 Medium File Asst 25-40 .06 25mm (4/pk)
2 Large File Asst 35-50 .06 25mm (4/pk)
1 Gutta Percha/Paper Points Asst Wheel .06 15-50
2 EndoSequence K-File Asst 8-20 .02 25mm (6/pk)
1 EndoSequence Chairside Guide
PROCEDURE
US : Shop.BrasselerUSA.com or 800.841.4522 | Canada : Shop.Brasseler.ca or 800.363.3838 79
SYSTEMS
K000032 US No. 2 4 701L - - - - - 2 4 Figure No. H1 H1 H33L H34L 6801 6379 6850 5850 H1 H1 Head Size (1/10 mm) 010 014 012 012 016 023 023 018 010 014 Cutting Length (mm) 1.0 1.4 6.0 3.5 1.6 4.2 10.0 10.0 1.0 1.4 Shank Type FG FG FG FG FG FG FG FG RA SURG RA SURG Quantity 1 1 1 1 1 1 1 1 1 1 Order No. 5008861U0 File/Tip ID Tip Size .04 Taper .06 Taper 21 mm 25 mm 31 mm 21 mm 25 mm 31 mm Small 30-15 5009144U0 5009145U0 5009146U0 5009150U0 5009151U0 5009152U0 Medium 40-25 5009147U0 5009148U0 5009149U0 5013268U0 5013269U0 5013270U0 Large 50-35 5018144U0 5018145U0 5018146U0 5013271U0 5013272U0 5013273U0 Extra-Large 55-80 5014385U0 5014386U0 5014387U0 - - -
Order No. 5014822U0
No. 5013324U0
Order
EndoSequence® Kits


EndoSequence® Starter Kit:
1 K000032 EndoSequence Access Kit
5 Expeditor 21 .04 16mm (4/pk)
5 Small/Extra-Small File Asst 15-30 .04 21mm (4/pk)
5 Small/Extra-Small File Asst 15-30 .04 25mm (4/pk)
5 Small/Extra-Small File Asst 15-30 .04 31mm (4/pk)
5 Medium File Asst 25-40 .04 21mm (4/pk)
5 Medium File Asst 25-40 .04 25mm (4/pk)
5 Medium File Asst 25-40 .04 31mm (4/pk)
5 Large File Asst 35-50 .04 21mm (4/pk)
5 Large File Asst 35-50 .04 25mm (4/pk)
5 Large File Asst 35-50 .04 31mm (4/pk)
5 Extra-Large File Asst 55-80 .04 21mm (4/pk)
5 Extra-Large File Asst 55-80 .04 25mm (4/pk)
5 KontrolFlex Stiff K-File 08 25mm (6/pk)
5 KontrolFlex Stiff K-File 10 25 (6/pk)
5 KontrolFlex
5
1
Order No. 5019354U0
EndoSequence® Complete Introductory System:
Order No. 5019355U0
PROCEDURE
80
SYSTEMS
Stiff K-File 15 25 (6/pk)
Gates Glidden Asst 50-150mm (6/pk)
BC Points/Paper Points Asst Wheel
15-60
EndoSequence Canal Clean (100mL)
EndoSequence Lubricant
EndoSequence BC Sealer
EndoSequence Chairside Guide
.04
1
1
1
1
1 EndoSequence Case 1 EndoSequence 2 Handpiece 1 EndoSequence 2 Addition Head 10:1 1 K000032 EndoSequence Access Kit 1 K0044 Small Rotary File Kit 30-15 .04 25mm 1 K0047 Medium Rotary File Kit 25-40 .04 25mm 1 K0129 Large Rotary File Kit 35-50 .04 25mm 5 Expeditor 21 .04 16mm (4/pk) 3 Small/Extra-Small File Asst 15-30 .04 25mm (4/pk) 6 Medium File Asst 25-40 .04 25mm (4/pk) 3 Large File Asst 35-50 .04 25mm (4/pk) 3 Extra-Large File Asst 55-80 .04 25mm (4/pk) 1 KontrolFlex K-File 08 25mm (6/pk) 1 KontrolFlex K-File 10 25 (6/pk) 1 KontrolFlex Stiff K-File 10 25 (6/pk) 1 KontrolFlex K-File 15 25 (6/pk)
KontrolFlex Stiff K-File 15 25 (6/pk)
KontrolFlex K-File 20 25 (6/pk)
BC Points/Paper Points Asst Wheel .04 15-60
EndoSequence Canal Clean (100mL)
EndoSequence BC Sealer
Curve Test Block
EndoSequence Chairside Guide
1
1
1
1
1
1
1
EndoSequence® Kits
EndoSequence® Intro Kit:

2 Expeditor 21 .04 16mm (4/pk)
2 Small/Extra-Small File Asst 15-30 .04 25mm (4/pk)

3 Medium File Asst 25-40 .04 25mm (4/pk)
2 Large File Asst 35-50 .04 25mm (4/pk)

1 BC Points/Paper Points Asst Wheel .04 15-60
1 EndoSequence BC Sealer
1 K0165 EndoSequence Restorative kit
1 EndoSequence Chairside Guide
Order No. 5023032U0
ESX® Kits
Order No. 5024555U0 K0284
US : Shop.BrasselerUSA.com or 800.841.4522 | Canada : Shop.Brasseler.ca or 800.363.3838 81
PROCEDURE SYSTEMS
US No. 1558SC 1557SC – – – 4 Figure No. H031RS H031RS 5909 6801DC 6856DC H1 Head Size (1/10 mm) 012 010 040 014 014 014 Cutting Length (mm) 4.0 3.9 1.0 – 8.0 RA SURG RA SURG Shank Type FG FG FG FG FG 1 Quantity 1 1 1 1 1
ESX® Modern Access Kit
ESX® Kits


ESX® Intro Kit:
5 ESX Expeditor 15 .05 25mm (3/pk)
2 ESX Small File 25 .04 25mm (3/pk)
3 ESX Medium File 35 .04 25mm (3/pk)
2 ESX Large File 45 .04 25mm (3/pk)
1 BC Points/Paper Points Asst Wheel .04 15-60
1 EndoSequence BC Sealer
1 ESX Chairside Guide
Order No. 5024346U0
K0281 ESX® Starter Kit:
15 ESX Expeditor 15 .05 25mm (3/pk)
5 ESX Small File 25 .04 25mm (3/pk)
10 ESX Medium File 35 .04 25mm (3/pk)
5 ESX Large File 45 .04 25mm (3/pk)
2 ESX Extra-Large File 55 .04 25mm (3/pk)
2 ESX Orifice Shaper 20 .08 19mm (3/pk)
2 ESX Scouting File 15 .02 25mm (3/pk)
2 ESX Scouting File 15 .04 25mm (3/pk)
5 KontrolFlex Stiff K-File 08 25mm (6/pk)
5 KontrolFlex Stiff K-File 10 25 (6/pk)
5 KontrolFlex Stiff K-File 15 25 (6/pk)
1 BC Points/Paper Points Asst Wheel .04 15-60
1 EndoSequence Canal Clean (100mL)
1 EndoSequence Lubricant
1 EndoSequence BC Sealer
1 ESX Chairside Guide
Order No. 5024347U0
PROCEDURE
82
SYSTEMS
BioRaCe™ Kits

K0220 BioRaCe™ Starter Kit:
5 KontrolFlex Stiff K-File 08 25mm (6/pk)
5 KontrolFlex Stiff K-File 10 25 (6/pk)
5 KontrolFlex Stiff K-File 15 25 (6/pk)
5 ScoutRaCe Asst 21mm (5/pk)
5 ScoutRaCe Asst 25mm (5/pk)
10 BR0-BR5 BioRaCe Basic Asst 21mm (6/pk)
5 BR4C-BR7 BioRaCe Extended Asst 21mm (4/pk)
10 BR0-BR5 BioRaCe Basic Asst 25mm (6/pk)


5 BR4C-BR7 BioRaCe Extended Asst 25mm (4/pk)
1 K0218 BioRaCe Access Kit
1 K0219 BioRaCe Chairside Block
1 BC Gutta Percha .04 15mm (60/pk)
1 BC Gutta Percha .04 35mm (60/pk)
1 BC Gutta Percha .04 40mm (60/pk)
1 BC Gutta Percha .04 50mm (60/pk)
1 EndoSequence BC Sealer (2g)
1 BioRaCe Chairside Card
1 ScoutRaCe Chairside Card
Order No. 5019731U0
BioRaCe™ Access Kit
Order No. 5020020U0
BioRaCe™ Chairside Procedure Block
K0219 Aluminum Block: Non-loaded Etched for Ideal BioRaCe Tray Setup
Order No. 5020021U0
US : Shop.BrasselerUSA.com or 800.841.4522 | Canada : Shop.Brasseler.ca or 800.363.3838 83 K0218 US No. - - - 4 2 Figure No. 6850 6801 H34L H1 H1 Head Size (1/10 mm) 023 016 012 014 010 Cutting Length (mm) 10.0 1.6 3.5 1.4 1.0 Shank Type FG FG FG FG SURG RA SURG Quantity 1 1 1 1 1
PROCEDURE SYSTEMS
Ultrasonic Tip Kit

K0209 Ultrasonic Tip Kit:
1 E4 Tip
1 E9 Tip
1 E9D Tip
1 E14D Tip
1 E15D Tip
1 A641 Black Aluminum Tip Caddy

Order No. 5019701U0
Post Kit
K0165 EndoSequence® Post Starter Kit (.04 Taper):

5 ea. (sizes .50-1.1) EndoSequence Posts (.04 Taper)
2 Double Ended Burnout Pluggers (.04 Taper)
1 Universal Finishing Diamond
1 Hand Driver
1 Instructions for Use (IFU)
Order No. 5015623U0
K0166 EndoSequence® Post Starter Kit (.06 Taper):
5 ea. (sizes .50-1.0) EndoSequence Posts (.06 Taper)
2 Double Ended Burnout Pluggers (.06 Taper)
1 Universal Finishing Diamond
1 Hand Driver
1 Instructions for Use (IFU)
Order No. 5015624U0
PROCEDURE
84
SYSTEMS
Aluminum Bur Blocks
A800 Aluminum Block: Holds: 20 Small, 10 Large





Order No. 5000989U0
A812
48 Large
Order No. 5008130U0
A822
Holds: 4 EndoSequence Files
Order No. 5009065U0
A803
Holds: 15 Small, 10 Large
Order No. 5000994U0
A825
Holds: 8 Large, 24 Small, 16 EndoSequence
Order No. 5013399U0
A641
Holds: 6 Ultrasonic Tips
Order No. 5019698U0

US : Shop.BrasselerUSA.com or 800.841.4522 | Canada : Shop.Brasseler.ca or 800.363.3838 85
PROCEDURE SYSTEMS
Aluminum Block:
Aluminum Block:
Aluminum Block:
Aluminum Block:
Aluminum Block: Holds:
Endo Solutions Caddy

Features 3 forward-angled slots for bottles, 3 large base compartments and slots to accomodate up to 12 syringes (8 x 3cc & 4 x 6cc).
Order No. 5026556U0
EndoRing® II
Organizer with Metal Ruler
• Single handed file organization
• Reduces cross contamination
• Minimizes file passing and risk of accidental puncture
• Autoclavable
EndoRing® II Kit

1 EndoRing® Assembly
12 Single-Use GelWell® Cups
48 e-Foam® Inserts
1 Metal Ruler
Order No. 5026399U0
e-Foam® Inserts (60/Pack)

Includes 30 yellow and 30 blue inserts
GellWell® Cups (48/Pack)

Order No. 5026400U0
Order No. 5026401U0
EndoRing®, GelWell® and e-Foam® are registered trademarks of Jordco, Inc.
ORGANIZATIONAL
86
SYSTEMS
EndoSwipe™
Intra-Oral File Cleaning Sponge (25/Pack)
• Proprietary design with tangle free foam

• No need to stop the rotary file
• Individual sterile packaging
Order No. 5024743U0
ORGANIZATIONAL SYSTEMS US : Shop.BrasselerUSA.com or 800.841.4522 | Canada : Shop.Brasseler.ca or 800.363.3838 87
88 NOTES
ENDODONTICS
Since 1976, our absolute focus has been to develop products and provide services that support the practice of core operatory procedures. Today, Brasseler USA® is the premier dental instrumentation company in North America offering the most extensive selection of dental and surgical instrumentation under one brand.












Visit our website at BrasselerUSA.com To order call 800.841.4522 or fax 888.610.1937. In Canada call 800.363.3838 B-5605-08.22-20M-RRD ©2022 Brasseler USA. All rights reserved. Printed in the U.S.A.
DIAMONDS
CARBIDES POLISHERS PROCEDURE SYSTEMS HYGIENE SMALL EQUIPMENT ORAL SURGERY HAND INSTRUMENTS LABORATORY INSTRUMENTS
HANDPIECES
BIOCERAMICS